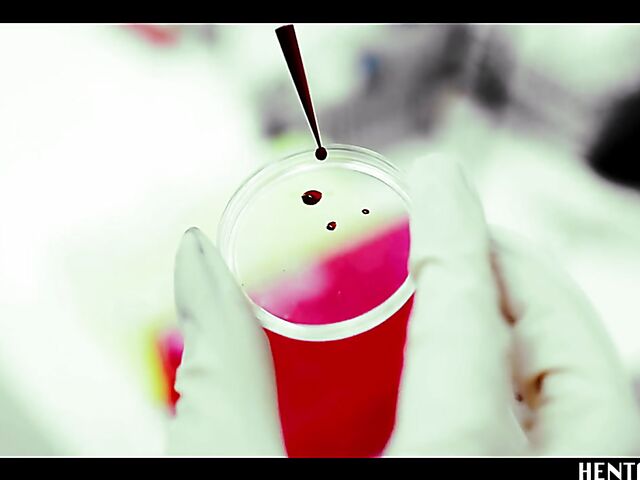
Alien sex with helpless Haneen who gets her shaved pussy filled

- All
- mature dildo
- lesbian toe sucking
- bubble butt
- japanese shemales
- czech amateur anal
- lesbian pool
- ebony teen interracial
- nipples clamp
- hairy dildo
- pov life
- sleeping lesbians
- anal sex pov
- hard anal pounding
- sex in the snow
- asian booty
- chubby lesbians
- two slaves
- french schoolgirl
- thick milf
- lady sonia interracial
- black threesome
- kinky amateur
- threesome compilation
- double penetration teen
- interracial pool
- bbw strapon
- chubby pov
- big tits bondage
- amateur beach
- spencer scott lesbian
- cory chase mom
- thai interracial
- boots solo
- amateur sex
- busty mom anal
- tranny blowjob
- group creampie
- euro mature
- mom seduces son
- bbc cum swallow
- ebony gangbang
- her first big cock
- mommy blowjob
- blue angel lesbian
- wetting pants
- busty spanish
- mature creampie
- anal strap on
- hot black girl
- ffm party
- tranny dp
- cum play
- huge tit
- amateur fingering
- pornstar webcam
- vintage interracial
- asian wife
- uncut cock
- thong tease
- daughter sex
- thick asian
- mouth compilation
- big tits creampie
- public pissing
- messy lesbian
- milf small tits
- dirty feet
- morning sex
- mouth cum
- pov orgasm
- couple masturbating
- college chick
- mirror masturbation
- public interracial
- small dick
- big white booty
- spanish hairy
- armpit licking
- virgin
- recorded webcam
- footsie babes
- fantasy sex
- blonde webcam
- madison scott lesbian
- lesbian hazing
- priya rai squirt
- cuckold slave
- hot body
- socks anal
- nude teen
- mackenzee pierce anal
- sucking bbc
- redhead dp
- cheating boyfriend
- busty mature anal
- very hard fuck
- big tits compilation
- cam
- bbw fingering
- mature facial
- british redhead
- saggy boobs
- handjob pov
- short hair lesbian
- young guy
- omar galanti anal
- teen redhead anal
- bbc cum in mouth
- asian fake tits
- busty milf anal
- deep throat pov
- amateur teens
- samantha ryan lesbian
- bound gangbang
- taboo handjob
- pov footjob
- remote control
- young pussy
- curvy lesbian
- spanish amateur teen
- car jerk off
- outdoor dp
- exploited teen
- erotica sex
- lesbian sport
- latina dildo
- step mom and son
- tight ebony
- huge tit milf
- teens analyzed
- perfect blowjob
- shower orgasm
- blow job
- asian gf
- huge naturals
- 3d toon
- black bitch
- milf big tits
- lesbian office
- stretched pussy
- dirty granny
- mom deepthroat
- bbw facesitting
- teen tugs
- rachel starr pov
- grinding on cock
- young dp
- hot handjob
- teaching blowjob
- black gag
- georgia jones lesbian
- dakota skye anal
- behind the scenes
- asian massage parlor
- eat ass
- breast kissing
- dildo gagging
- two girls one guy
- desi couple
- beach lesbians
- hanging tits
- anal play
- girl fucks guy
- black on asian
- lesbian bathroom
- licking
- korean porn
- british rough
- big clit
- indian couples
- curvy mom
- asian smoking
- wife riding
- milf young boy
- faucet masturbation
- gyno chair
- bbw shower
- ass compilation
- czech amateurs
- japanese dildo
- czech outdoor
- interracial anal creampie
- alexa tomas anal
- backroom facials
- wife watches husband fuck
- nudist beach
- asian pov
- dancing bear facial
- busty petite
- nikki blonde
- babysitter creampie
- czech street
- latina teen
- indian pussy
- black dick
- tokyo teen
- hunky
- masturbate and pee
- van anal
- lesbian strippers
- crazy milf
- lesbian whipping
- teen foot
- nerdy amateur
- beautiful solo
- busty friend
- schoolgirl public
- backroom facial
- deep throat fuck
- teen glasses
- young teen anal
- ripped pantyhose
- cute handjob
- naughty
- dirty talk masturbation
- anal destroyed
- paid for sex
- gina gerson gangbang
- curvy brunette
- pov cumshot compilation
- teen facial
- own cum
- blonde babe
- pussy licking orgasm
- feet joi
- creamy pussy cum
- public sex
- mature wife
- young hairy
- twistys lesbian
- old man asian
- kleio valentien anal
- tied up and fucked
- milf strapon
- cum in mommy
- abigail mac anal
- big tits masturbation
- amateur face fuck
- lesbian sister
- huge tits ebony
- oil fuck
- toilet masturbation
- gangbang compilation
- bbw big tits
- megan rain anal
- chinese anal
- busty mexican
- fingering together
- homemade webcam
- bukkake swallow
- amazing anal
- morning handjob
- latina slave
- petite anal
- joi big tits
- juelz ventura lesbian
- hairy dp
- big tits webcam
- lesbian strap on
- beautiful japanese
- ultimate surrender
- christy mack blowjob
- live sex
- japanese anal dildo
- candice dare anal
- japanese boobs
- big tits handjob
- mature ass
- pregnant masturbation
- french milf gangbang
- bridgette b threesome
- busty blonde
- isis love interracial
- adult baby
- public compilation
- leggings squirt
- mom sucks son
- lesbian maid
- mom massage
- hairy interracial
- big naturals anal
- busty gf
- big cock surprise
- sleeping blowjob
- male pornstars
- sister sex
- drunk slut
- bbc dp
- casting couch teen
- friends wife
- mommy blows best
- young big tits
- caught jerking
- pov titjob
- beach masturbation
- incredible blowjob
- hd interracial
- cowgirl compilation
- skinny fake tits
- step daughter anal
- tiny tits anal
- big boobs milf
- milf teen threesome
- alexis crystal anal
- fishnet porn
- busty lucy
- anal sluts
- german dp
- mom dildo
- asian white cock
- public bdsm
- femdom tease
- teen porn
- czech prostitute
- peeing girls
- kagney linn karter threesome
- natural teen
- big ass lesbian
- hot girl
- ebony girl
- anal masturbation
- midget lesbian
- hairy mature big tit
- rocco orgy
- amirah adara anal
- big ass anal
- sister seduces brother
- amateur squirting
- step mom pov
- alura jenson lesbian
- cameltoe panties
- brunette creampie
- skinny petite
- tight anal
- femdom cumshot
- interracial gang
- aletta ocean dp
- bikini babe
- interracial double
- swingers party
- 4some
- office slut
- gangbang swallow
- interracial threesome
- nerd teen
- piercing
- fucking a stranger
- dutch milf
- tiny teen big cock
- black cuckold anal
- mainstream sex scene
- maya handjob
- amateur ffm
- interracial bisexual
- wife fucks another man
- simony diamond anal
- lesbian toe fucking
- huge natural tits
- old and young anal
- huge cocks
- mother son pov
- pregnant teen
- teen dildo ride
- creampie swallow
- ebony throat
- granny dildo
- juicy ass
- arab ass
- lesbian mud
- hairy teen anal
- sporty teen
- amateur anal threesome
- latina squirting
- craves black cock
- red head teen
- interracial blow bang
- amateur orgasm
- milf mom
- see through panties
- brutal throat
- bbw gangbang
- ebony threesome
- skinny ebony anal
- busty threesome
- old granny pussy
- kinky wife
- young masturbation
- panties porn
- lisa ann lesbian
- piper perri interracial
- amateur trib
- foot sex
- latina rough
- classic porn
- taxi fuck
- gia dimarco anal
- seduced by a cougar
- sleeping milf
- asian maid
- bbw foursome
- czech fantasy
- bbw granny
- wax
- cum twice
- meet and fuck
- bent over
- cute chubby
- maid porn
- strapon threesome
- german cum
- rough casting
- blonde daughter
- milf teen lesbian
- pov cum
- bbw rough
- ebony girls
- ass worship pov
- mature big boobs
- amateur tied
- hot lesbian kiss
- public threesome
- porn for women
- milf hunter
- onion booty
- blonde rough
- busty foursome
- black teen girl
- lesbian kiss
- homemade rimming
- perfect body
- sister threesome
- interracial lesbians
- hot milf next door
- vibrator orgasm
- funny sex
- skinny redhead
- back room
- interracial lesbian threesome
- outdoor gangbang
- loose pussy
- laras playground
- amateur lesbian 69
- drunk lesbian
- street pick up
- italian amateur
- german mature
- bbw bikini
- french bukkake
- maid big tits
- stunning blonde
- huge tits asian
- blonde nurse
- blacked teen
- homemade ass
- asian face fuck
- natalia starr solo
- anal bet
- sindee jennings squirt
- busty blonde anal
- busty japanese lesbians
- perfect tits
- hard face fuck
- car pov
- blowjob lesson
- girl masturbates in
- amateur handjob compilation
- sex and submission anal
- chubby blowjob
- oil porn
- alexis texas ass
- german compilation
- midgets
- amateur facial compilation
- caught watching
- hairy pregnant
- pornstar compilation
- accidental anal
- anissa kate interracial
- cute anal
- saggy tits
- french bdsm
- beautiful shemale
- chubby latina
- interacial anal
- fake ass
- asian pantyhose fuck
- huge black dick
- german foursome
- fffm blowjob
- shower solo
- whore wife
- blowjob gangbang
- tiny brunette
- japanese pov
- honey moon
- amazing body
- nudist family
- pantyhose seduction
- young tiny teen
- bbw hardcore
- ebony lesbians
- balls deep anal
- amateur milf
- pierced nipple
- indian cuckold
- athletic girl
- young and old
- valentina nappi lesbian
- black ebony
- big booty gangbang
- lesbian nina
- chubby compilation
- kinky lesbian
- drunk teen
- tattoo interracial
- asian webcam
- well hung
- first time handjob
- lesbian softcore
- wet pussy orgasm
- fake cop
- amateur double penetration
- sweaty sex
- pigtails anal
- glamorous
- hairy pussy close up
- femdom bondage
- hairy asian
- lost bet
- fake agent anal
- electro bdsm
- ebony masterbating
- big ass german
- fat ass
- russian orgy
- big butt milf
- big booty dp
- great blowjob
- girlfriends mother
- water masturbation
- chanel preston anal
- tranny cheerleader
- chubby anal
- bonnie rotten anal
- british anal
- watching girlfriend
- ebony mom
- pee drink
- silicone boobs
- ebony latina
- shower threesome
- her first anal
- pumping
- wife interracial anal
- hot blonde milf
- underwather
- old lesbians
- granny masturbates
- teen public
- mature pierced
- milf blowjob pov
- daddys friend
- mature fingering her
- prolapse party
- black cock compilation
- lesbian photo shoot
- janet mason mom
- suck
- bbw titfuck
- amateur handjob
- muscle anal
- cash for sex
- leather ass
- ass lick
- french cuckold
- sleeping wife
- homemade footjob
- condom cum
- party fuck
- mature gangbang
- sleeping teen
- misha cross anal
- big tits cam
- brandi love creampie
- tit job
- shemale masturbation
- big booty blonde
- anal acrobats
- dripping wet pussies
- homemade couple
- art lingerie
- vintage orgy
- homemade mmf
- eloa lombard anal
- pissing girls
- august ames threesome
- lesbian lap dance
- interracial teen anal
- petite thai
- car sex
- changing room sex
- ebony amateur
- lady sonia handjob
- brazilian big ass
- anal deepthroat
- naked sport
- amateur hardcore
- foot massage
- busty babe
- michelle thorne anal
- shemale fucks girl anal
- rough teen
- big ass blonde
- busty milf pov
- big natural tits dp
- ebony teen lesbian
- lesbian army
- huge strap on
- bisexual teens
- amateur blonde milf
- fucked to orgasm
- femdom ass licking
- bodybuilder sex
- teen orgasm
- anal cowgirl
- milking tits
- nails
- bisexual swingers
- camel toe
- eat hairy pussy
- thai teen
- lesbian sybian
- old nanny
- strip poker
- huge dildo
- bibi noel anal
- under table blowjob
- bondage orgasms
- mom teen
- old young creampie
- over 60
- hairy blonde teen
- nylon footjob
- tight fuck
- big ass gangbang
- blonde ffm
- anal humiliation
- lesbian lesson
- shower fuck
- milf outdoor
- gay fetish
- cute casting
- tied tits
- japanese old man sex
- chanel preston interracial
- brazilian ass
- rachel roxxx creampie
- armenian porn
- oily handjob
- curly brunette
- asian bbc
- czech streets
- piss swallow
- amateur housewife
- secretary solo
- cinema fuck
- asian big booty
- street pickup
- cosplay solo
- blowjob for money
- ebony boobs
- daughter spanked
- russian blonde teen
- august ames lesbian
- long tongue blowjob
- black slut
- fishnet solo
- mom helps son
- lingerie lesbians
- pussy eating
- gangbang audition
- nubile
- femdom piss
- pantyhose feet
- water bondage
- real whore
- moms boyfriend
- czech first video
- my dirty maid
- riley steele lesbian
- latina teen anal
- jiggling tits
- ebony nerd
- amateur brunette
- bbw victoria
- screaming wife
- riley reid dp
- teen fucked
- humiliation femdom
- big nipples
- friends son
- big ass mom
- pussy exam
- jacking off
- amateur interracial creampie
- tit fuck
- big tits blonde
- homemade bbc
- lesbian piss
- french anal fisting
- golden shower
- kinky jo
- lesbian casting
- short hair brunette
- skinny dp
- blowjob under the table
- short hair bbw
- slave boy
- teacher fuck student
- japanese ass
- sybian orgasm
- japanese ffm
- virtual sex pov
- foot fucking
- mother daughter threesome
- jenna haze anal
- ebony compilation
- big tits orgasm
- milf hooker
- big black cock anal
- milf seduces young girl
- mega boobs
- oiled handjob
- casey calvert anal
- lesbian sauna
- teen gang bang
- nylon slave
- machine bondage
- retro interracial
- kelsi monroe anal
- manuel ferrara teen
- skinny teen webcam
- big tit amateur
- gyno exam
- fuck while talking
- skinny pov
- curvy girlfriend
- beautiful brunette
- swinger party
- cute girl sex
- bbc deep throat
- college fuck
- old couple fuck teen
- amateur gangbang
- gorgeous teen
- chinese bondage
- downblouse tits
- indian cum
- australian lesbian
- ginger anal
- my first sex teacher
- black cock in ass
- beauty and the senior
- teen hitchhikers
- latina hooker
- pink nipples
- anal foursome
- anal insertion
- japanese small tits
- mom and son fuck
- homemade ffm
- nipple play
- brazilian booty
- wow girls anal
- asian teen masturbation
- interracial double anal
- retro teen
- pantyhose threesome
- british casting
- public fucking
- fucked in pantyhose
- asian beaver
- casting x
- double blowjob
- busty latina milf
- wifeys world
- lex steele anal
- masturbating to porn
- black ass anal
- small tits ebony
- linda sweet anal
- finger orgasm
- penny pax interracial
- cumming inside
- veronica avluv interracial
- slime wave
- porn backstage
- black solo
- anal whore
- lesbian love
- piss compilation
- petite schoolgirl
- busty maid
- shy japanese
- megan rain interracial
- dads girlfriend
- stella cox anal
- dirty teen
- amateur bi
- doggy cum
- redhead big tits
- amateur deepthroat
- high school teen
- lesbian oil
- big boobs wife
- nurse handjob
- blond anal
- mom teaching teen
- cum filled
- sexy legs solo
- ebony milf
- friends hot mom
- old pervert
- japanese cfnm
- nude sports
- double headed dildo
- big tits maid
- milf and teen lesbian
- german redhead teen
- pee shower
- farting girls
- farm sex
- double-teamed
- big man
- schoolgirl threesome
- black gf
- curly redhead
- joslyn james interracial
- drunk sex party
- creamy masturbation
- black muscle
- interracial doggy
- indian squirt
- hot ass
- gape
- too big
- big boob mom
- big round ass
- sexy latina
- tori black threesome
- webcam foursome
- cayenne klein anal
- japanese nude
- big dick teen
- best doggystyle
- little ass
- shemale bdsm
- black ass licking
- fan fuck
- milf interview
- huge black cock
- foot fetish anal
- public anal
- young and old lesbians
- upskirt masturbation
- sextoy
- cum on her face
- vintage full movie
- magic wand
- ashlynn brooke pov
- amateur black couple
- ebony small tits
- casting interracial
- busty girlfriend
- rimming
- adrianna nicole anal
- homemade spanking
- suction dildo
- lesbian prolapse
- real public sex
- shyla jennings lesbian
- fitness babe
- strapon pov
- drunk lesbians
- public handjob
- heel insertion
- pale bbw
- teen first
- extreme anal insertions
- german maid
- japanese domination
- nude beach
- skinny wife
- van fuck
- wife sex
- white teen black cock
- pregnant solo
- blindfolded tricked
- cheerleader gangbang
- shower blowjob
- college orgy
- lesbian tattooed
- mexican mom
- tiny tits teen
- 69
- asian blowjob
- old sex
- jennifer dark anal
- indian doggy
- milking cock
- asian tied
- mom teaching daughter
- baseball bat anal
- internal cumshot
- blonde anal
- panty solo
- lisa ann anal
- milf interracial
- cock rubbing pussy
- tied orgasm
- skirt fuck
- tonight girlfriend
- public beach sex
- ebony teen
- busty milf teacher
- brunette gangbang
- model anal
- huge white dick
- blonde housewife
- japanese dp
- angel anal
- perfect ass anal
- big tits ffm
- big tits hairy pussy
- cable guy
- pussy dildoing
- teen pee
- homemade masterbation
- latina squirt
- art of sex
- wife anal
- anal squirting
- busty skinny
- hotel threesome
- bbw mistress
- hairy pussy
- remote control vibrator
- college anal
- beautiful teen anal
- little caprice lesbian
- teen cum
- ssbbw anal
- black girl white guy
- mature woman
- bdsm dp
- tranny domination
- mature group sex
- bathtub masturbation
- big areolas
- old and young threesome
- lesbian tied up
- black hairy pussy
- syren de mer lesbian
- shawna lenee threesome
- cuckold domination
- tiny blonde teen
- girlfriend footjob
- big tits cougar
- wild sex
- anal kitchen
- reverse gangbang anal
- british hairy
- first time threesome
- teen for cash
- keiran lee anal
- messy facial
- library sex
- brianna love anal
- busty british
- huge oiled tits
- french anal milf
- dirty talking teen
- cock ring
- webcam anal couple
- sybian teen
- ass gape
- lesbian roommates
- asian shower
- latina bikini
- mature squirt
- blonde anal creampie
- bottle insertion
- 50 plus milf
- british pov
- ariana marie solo
- hardcore casting
- interracial dp gangbang
- boobs compilation
- pussy slapping
- black white couple
- lesbian blonde
- lesbian pornstars
- blonde maid
- ivana sugar anal
- short hair ebony
- milf lesbian strapon
- big tit secretary
- painful anal
- moms teach sex
- curvy ebony
- lesbian stepmother
- japanese family sex
- japanese submissive
- blonde shemale
- bbc slut
- skinny ebony
- ebony swallow
- indian couple
- pov cuckold
- sabrisse a
- hairy german
- destroyed anal teen
- dildo chair
- brazilian pornstar
- hard spanking
- hot blonde anal
- sister jerk
- slumber party
- strapon solo
- hairy redhead
- lesbian sleepover
- riley reid black
- short haired blonde
- girl gone wild
- cathy heaven interracial
- riding compilation
- nurse threesome
- african amateur
- perfect girl
- three girls one guy
- milf dildo
- hairy masterbation
- ebony teen amateur
- bbw and bbc
- white whore
- bikini porn
- homemade foursome
- bbw huge boobs
- mia khalifa interracial
- hairy fisting
- latina lesbian
- club orgy
- feel myself
- extreme bdsm
- husband watches
- brutal machine
- aletta ocean gangbang
- teen escort
- carter cruise anal
- blonde deepthroat
- anal gang bang
- wife cuckold
- ass cumshot
- tina hot anal
- foot mistress
- latina orgasm
- ariel x lesbian
- mom and daughter bbc
- mature pornstar
- erotic blowjob
- cfnm fuck
- indian sex tape
- bbw skirt
- atm threesome
- brutal dp
- brutal deepthroat
- military lesbian
- skinny teen solo
- black gangbang
- teen rimming
- webcam ass
- anal lick
- dana vespoli anal
- british bukkake
- tease
- eve angel solo
- double fuck
- filled with cum
- bottle anal
- horny asian
- orgasmic convulsions
- old and young lesbian
- tiny asian girl
- thong fuck
- fleshlight cum
- african interracial
- filthy family
- bbw maid
- school uniform
- black pussy squirt
- ebony pornstar
- busty housewife
- luna star anal
- british dirty talk
- blonde ass
- keisha grey anal
- only teen blowjobs
- office anal
- ebony prostitute
- ebony rough
- double footjob
- busty lingerie
- bisexual foursome
- feet sucking
- bbw sucking cock
- pantyhose fuck
- i feel myself
- curvy amateur
- strapon mistress
- lisa ann lingerie
- ass licking
- thick white
- nasty mature
- dildo ass
- two teens
- ebony stepsister
- francesca le pov
- sarah jessie anal
- amateur emo
- screaming teen
- spread legs
- romain
- lesbian mom
- tricky masseur
- hitachi orgasm
- homemade wife
- classic dp
- french chubby
- ffm big tits
- girlfriend mom
- lesbians squirting
- oral creampie
- spanish blowjob
- latex bondage
- teen latina anal
- homemade handjob
- clothed sex
- throat fuck
- small ass
- russian interracial
- big natural tits pov
- cosplay pov
- fight
- girls out west
- teen facial compilation
- black cock creampie
- fake doctor
- latina solo
- dancing bear cumshot
- thai handjob
- busty lesbians
- lesbian fist
- topless teen
- interracial fisting
- cheerleader interracial
- busty mother
- nude on stage
- asian facial
- mature amateur anal
- lesbian yoga
- lethal hardcore
- first lesbian experience
- maid pov
- mistress t mom
- sexy vanessa bella
- big tits milf
- pov squirt
- sophie lynx anal
- amateur stripping
- first time auditions
- oiled ebony
- battle bang
- drunk blonde
- round boobs
- lesbian mistress
- her first lesbian sex
- teen anal pov
- blonde gangbang
- japanese vibrator
- india babe
- elexis monroe lesbian
- young amateur
- nuru massage
- leg shaking orgasm
- japanese old man
- blonde milf pov
- gina gerson lesbian
- best friends mom
- homemade double penetration
- mom double
- rough strapon
- swinger wives
- missionary fuck
- tits anal
- gym threesome
- blowjob swallow
- wrestling fetish
- african lesbian
- petite blonde anal
- tattoo anal
- wet pussy fuck
- mature kitchen
- tranny fucks guy
- indian masturbation
- first time lesbian
- smoking porn
- skinny black girl
- hardcore dp
- japan schoolgirl
- lorelei lee bdsm
- blonde teen blowjob
- pussy spanking
- messy deepthroat
- bottle
- big clit masturbation
- huge tits granny
- beautiful dp
- lesbian big tits
- dildo squirt
- public nudity
- office dp
- veronica rodriguez lesbian
- pov compilation
- lesbian strapon anal
- mature masturbating
- petite pov
- ex wife
- brooke wylde interracial
- cute blonde teen
- hot bush
- cute lesbians
- hairy pussy creampie
- black big tits
- desi aunty
- amateur cam
- mature strip
- blindfolded bdsm
- bathroom blowjob
- massive anal
- naughty allie
- jerk off instructions
- veronica avluv anal
- teen deepthroat
- bathroom solo
- chinese teen
- slim blonde
- femdom anal fisting
- gloryhole anal
- french fisting
- mature and teen lesbian
- phoenix marie interracial
- watching guy jerk off
- claudia valentine anal
- mature fisting
- reverse cowgirl
- punk anal
- bathroom pov
- big nipple
- pantyhose gangbang
- naughty schoolgirl
- 19 years old
- team skeet
- dirty maid
- mckenzie lee anal
- asian femdom
- pissing outdoor
- best teen
- lesbian amateurs
- black teen anal
- hot milf
- amateur kitchen
- oral gangbang
- busty hairy teen
- glasses masturbate
- toes licking
- amateur doggy
- first facial
- busty amateur
- latina feet
- giant anal
- pussy flash
- gia dimarco bdsm
- lesbian strapon squirt
- big natural tits lesbian
- asian sex
- valentina nappi dp
- hairy masturbation
- best deepthroat ever
- huge saggy tits
- busty milf solo
- teen blowjob
- job interview
- cherie deville interracial
- bbw schoolgirl
- little pussy
- fisting guy
- huge white ass
- latina bbw
- skinny daughter
- big natural tits
- gorgeous asian
- hypnotized fuck
- chanel preston dp
- hot amateur
- white bbw
- street nude
- latina gangbang
- asian slave
- dark skin latina
- close up pussy licking
- milf strap on
- anal plug
- teeny lovers
- barely legal teen
- midget fucks girl
- japanese bikini
- latin lesbians
- big tit teacher
- thai whore
- japanese milf
- kagney linn karter interracial
- big ebony tits
- pussy closeup
- cuckold blonde
- riley reid squirt
- glasses gangbang
- shemale tits
- perfect webcam
- wedding fuck
- ffm compilation
- ebony bbw
- real gf
- anal virgin
- perfect natural
- big saggy tits
- old man young girl anal
- shaved granny
- russian amateur
- nylon fuck
- naked in public
- oil anal
- pale hairy
- kendra lust interracial
- redhead pov
- sucking brother
- filipina milf
- skinny porn
- czech busty
- anal slut
- indian couple sex
- teen cumshot
- busty office
- busty milf young boy
- ebony shemale
- caning punishment
- sloppy pussy
- mature mmf
- lusty grandma
- hot g vibe
- huge tits interracial
- milf seduces
- ava addams interracial
- shemale bareback
- mmf threesome
- tries anal
- german group sex
- stripper
- doggystyle anal
- busty brunettes
- anal prolapse
- cum louder
- sweet victoria
- ebony bbw solo
- julie cash interracial
- she cums
- old young orgy
- mega tits
- monster cumshot
- angela white interracial
- hot lesbians
- secret fuck
- deepthroat swallow
- busty black
- glory hole amateur
- tattooed pov
- interracial lesbian domination
- syren de mer interracial
- party hardcore
- japanese outdoor
- daughter blowjob
- japanese cheating wife
- mature sucking
- lesbian beauty
- sexy legs
- lesbian girlfriend
- lesbian family
- anal creampie amateur
- asshole massage
- thai prostitute
- twerk teen
- german stockings
- milf slut
- black squirt
- mom riding
- first fisting
- south indian
- sasha grey machine
- thai tits
- sensual handjob
- skye blue
- asian compilation
- tricked into sucking
- alura jenson interracial
- japan uncensored
- japan beauty
- fuck date
- french mature amateur
- first anal
- bbw big dildo
- hairy milf anal
- indian gangbang
- adriana chechik squirt
- petite russian
- pornstars fuck fans
- lisa ann interracial
- breath control
- casting couch threesome
- swedish amateur
- big lesbian
- japanese lesbian
- fisting teen
- midget girl
- blacks on cougars
- mature group
- public sex for cash
- mom and daughter threesome
- cuckold compilation
- family orgy
- her first gangbang
- dirty daughter
- amateur ffm threesome
- sierra anal
- naked beach
- czech beauty
- lesbian squirt orgy
- mom dirty talk
- blonde footjob
- barley legal
- cute latina
- anna polina anal
- housewife solo
- maid caught
- ebony slave
- czech whore
- chubby amateur
- wife public
- bbw booty
- amateur pantyhose
- yoga sex
- webcam big boobs
- massage handjob
- interracial gangbang creampie
- german webcam
- flexible anal
- lesbian caught
- best ass compilation
- first monster cock
- sisters
- mature pov blowjob
- vintage blowjob
- brunette big tits
- ebony big ass
- old and teen
- torbe amateur
- ebony fisting
- feet fuck
- petite latina anal
- bikini lesbian
- lesbian lingerie
- ebony escort
- swimming naked
- strapless dildo
- homemade fisting
- cum on tits compilation
- blowjob on the phone
- tied and gagged
- sex addict
- hot couple
- massive ass
- christy charming
- bar fuck
- strapon gangbang
- interracial bukkake
- stockings footjob
- femdom face sitting
- shane diesel interracial
- milf natural tits
- big tits mature solo
- asa akira lesbian
- romi rain lesbian
- femdom lesbian
- latina maids
- sex tape
- czech swingers
- asian big black
- veronica avluv mom
- spandex ass
- mom blows son
- ava addams threesome
- teen fingering solo
- lick
- blowjob mistress
- bdsm gangbang
- pretty teen
- masseuse handjob
- old guy young girl
- ebony stepdaughter
- mom anal
- nude gymnastics
- long legs
- tribbing lesbians
- interracial gloryhole
- aj applegate interracial
- ass anal
- granny and boy
- beautiful eyes
- friends masturbate
- face riding
- real lesbians
- wild fuck
- shemale webcam
- phoenix marie threesome
- tattoo blonde
- skinny redhead teen
- desi teen
- feet worship
- forest anal
- lesbian bride
- anal audition
- flat chested anal
- mom casting
- busty cougar
- nasty anal
- multiple facial
- gym solo
- beautiful ebony
- gloryhole deepthroat
- black butt
- cute teen casting
- topless handjob
- mom slave
- milf shower
- bailey blue anal
- creamy orgasm
- asian boobs
- teen threesome
- 90s pornstars
- lesbian licking
- milf pov
- punk teen
- teen first anal
- busty slut
- bisex orgy
- teen big tits
- arab mom
- pale skin
- cum in mouth compilation
- first lesbian sex
- feet young girl
- hot aunt
- japanese schoolgirls
- fascinating
- monique alexander lesbian
- rubber slave
- glasses blowjob
- daughter creampie
- nice natural tits
- self fisting
- wife fucked
- big ebony
- german slut
- prolapse fuck
- ass masturbation
- big tit girlfriend
- spring break fuck
- mick blue anal
- daddy anal
- busty japanese
- bbc blowjob
- oil sex
- lisa ann gangbang
- prince yahshua anal
- neighbor milf
- tight black pussy
- living with anna
- skinny asian
- gorgeous brunette
- classic rocco
- milf lesbians
- cuckold humiliation
- aussie lesbians
- bubble butt ebony
- ffm
- interracial foursome
- bound lesbian
- milf and young boy
- chubby milf
- eva black anal
- tiny redhead
- teen monster cock
- french amateur anal
- flashing pussy
- exploited college girls anal
- chick with dick
- lesbian big boobs
- euro teens
- clothed anal
- bondage solo
- skinny interracial
- watch you jerk
- black teens
- big tits amateur
- busty teen
- busty indian
- extreme gangbang
- indian aunty blowjob
- kristina rose interracial
- polish mature
- granny porn
- big tits mistress
- sisters friend
- shemale shower
- teen pov
- curvy anal
- femdom anal
- leggings anal
- milking table
- daddies
- foot fetish pornstar
- busty german milf
- double vag
- teen masturbation
- kiera king interracial
- massive load
- hot ebony
- bath sex
- sex in car
- mature natural tits
- japanese sex
- piss in ass
- skinny big tits
- mature interracial gangbang
- jenaveve jolie threesome
- latina wife
- slutty wife
- asian latex
- ebony huge tits
- cock worship
- busty sleeping
- actress sex scene
- lesbian twins
- big tit interracial
- webcam babe
- euro teen
- hairy piss
- lesbian game
- hairy redhead teen
- lesbian strapon threesome
- asian outdoor
- asian handjob
- machine
- threesome ffm
- lesbian lick
- beach couple
- cam couple
- curvy teen
- cuckold hotwife
- chubby masturbating
- slim granny
- amateur lesbian orgy
- teacher gangbang
- thick cock
- wrestling lesbian
- sleeping mature
- burning angel anal
- skinny thai
- busty bbw anal
- dirty talking slut
- masturbation squirt
- old young amateur
- big black cock teen
- brazzers office
- reality sex
- booty shake
- mature roxy
- tiny dick
- jelena jensen lesbian
- girlfriend anal
- intense anal
- amateur anal
- shemale joanna jet
- japanese idol
- cute teen solo
- picked up and fucked
- skinny small tits
- nina elle interracial
- perfect black ass
- bizarre extreme
- milf anal dildo
- quick blowjob
- asian solo
- shemale cumshot compilation
- voyeur sex
- sex positions
- femdom ass worship
- 40 plus milfs
- small tits pov
- blonde wife
- aletta ocean threesome
- phat ass
- homemade orgy
- watch masturbate
- anal fisting teen
- jessica jaymes lesbian
- strip club fuck
- british squirting
- lesbian babes
- amateur bbw interracial
- ariella ferrera lesbian
- piss on cock
- sloppy blowjob
- bbw pool
- bbw dp
- titjob
- redhead casting
- nice tits
- amy brooke anal
- lesbian group
- asian shemale
- sasha grey anal
- huge tits mom
- piss slave
- ugly teen
- tantric massage
- dana dearmond lesbian
- mature nurse
- big cock anal
- handjob domination
- blonde facial
- creampie slut
- blonde japanese
- ass shake
- ebony anal sex
- upskirt panties
- big boobs mature
- big naturals
- bisexual couples
- busty daughter
- ass rimming
- indian fuck
- lesbian tits
- wet porn
- amateur masturbating
- italian slut
- lisa daniels lesbian
- reverse cowgirl anal
- jada stevens pov
- big tits in sports
- pale blonde
- chubby couple
- face fuck
- wet and puffy
- big booty solo
- facial fest
- fuck team five
- milf bondage
- wow girl
- softcore
- stockings interracial
- big tits bbw
- colombian milf
- blonde teen dp
- cumswap
- lesbian feet
- big boob threesome
- huge load
- mr marcus anal
- sex education
- foot fisting
- close up blowjob
- desperate amateur
- black cock worship
- taboo family
- red head milf
- homemade fuck
- amateur group sex
- amateur facefuck
- little caprice anal
- shay fox lesbian
- two girls handjob
- mom facial
- latina interracial
- hailey young interracial
- nerd lesbian
- russian dp
- burning angel
- webcam dildo
- bbw mom
- sell your girlfriend
- blonde ebony
- busty brown
- blonde teens
- megan rain pov
- panty masturbation
- drunk sex orgy
- blowjob cum
- slut granny
- pale anal
- porn behind
- lesbian affair
- milf blowjob
- eat own cum
- dakota skye threesome
- naked ebony
- slow anal
- group anal
- brown bunny
- black and white lesbian
- bridgette b dp
- big boobs pov
- blonde schoolgirl
- amateur bbw anal
- latex sex
- threesome blowjob
- nude exercise
- young anal
- busty baby dolls
- mature amateur wife
- teen anal threesome
- amateur head
- extreme gagging
- black and latina
- homemade gangbang
- bathroom threesome
- mexican teen
- deep anal fisting
- talking dirty
- pegging strap on
- amateur couple
- young couple anal
- orgasmic contraction
- asian lingerie
- granny solo
- old dick
- black stripper
- homemade squirt
- pov creampie
- short hair stockings
- big breasted mature
- prostate massage
- fatty
- african hairy
- booty solo
- stud
- lela star pov
- hairy squirt
- jodi taylor anal
- hottest milf
- kitty jane anal
- fuck my husband
- foot threesome
- skinny dipping
- big tits casting
- young deepthroat
- real homemade
- chubby ebony
- milf wife
- redhead creampie
- black stepmom
- naked in the woods
- thai bbc
- homemade solo
- german teen gangbang
- mature ebony
- nubiles solo
- latex bdsm
- blonde mature mom
- femdom smother
- spandex porn
- hairy schoolgirl
- cum slave
- bootylicious bbw
- old vs young
- big tits anal
- chubby blonde milf
- girl do porn
- first anal sex
- elle alexandra lesbian
- ebony strapon
- raylene mom
- bare ass
- japanese schoolgirl
- cheating husband
- ass spanking
- amateur anal sex
- jim slip teen
- rough creampie
- mature blowjob
- alysa anal
- rimjob
- lingerie fuck
- big boobs webcam
- slim big tits
- bachelorette party
- japanese compilation
- mature feet
- teen first bbc
- bbw anal pov
- homemade blowjob
- tall asian
- mature lesbians
- pov big tits
- big tits chubby
- huge natural boobs
- ebony cum
- ebony anal compilation
- anal gape
- sharing wife
- rough gagging
- agent stockings
- twerk fuck
- dirty talk solo
- busty deepthroat
- clit massage
- husband watch black
- office threesome
- chinese femdom
- 18 years old
- sleeping guy
- ukrainian teen
- veronica rodriguez pov
- milf squirt
- solo spread
- indian mom
- lisa ann masturbation
- carmella bing threesome
- long nipples
- park bench
- milk enema
- barefoot fuck
- bbc anal creampie
- girl fingered
- glasses interracial
- kissing girls
- blowjob tease
- natural milf
- german ffm
- busty japanese teen
- three cocks
- cum in pussy
- asian anal gangbang
- gabriella paltrova anal
- interracial cartoon
- sex swing
- natasha nice anal
- valentina nappi solo
- black slave girl
- black whore
- girlfriend riding
- czech public
- gymnasts anal
- nebraska coed
- anal threesome
- femdom pegging
- redhead girlfriend
- black chick white dick
- big boobs amateur
- rough squirt
- girlfriend dp
- sister interracial
- lesbian fisting
- milf escort
- two shemales
- big butt anal
- aaliyah love solo
- dragon dildo
- flexible blonde
- tranny solo
- masturbating outside
- big natural ebony
- japanese bunny
- interracial bondage
- vintage flash
- classroom orgy
- webcam mom
- horse cock dildo
- sisters hot friend
- ssbbw interracial
- road trip
- femdom strap on
- short hair teen
- pov anal creampie
- small tits anal
- big tit nurse
- amazing deepthroat
- street hooker
- chinese pov
- teen bbc
- black webcam
- ebony cum swallow
- busty nurse
- tanner
- czech amateur
- real lesbian
- huge melons
- pale brunette
- russian anal
- young natural tits
- outdoor blowjob
- lesbian prison
- couple orgasm
- bisexual anal
- gorgeous blonde
- sofa
- medium boobs
- skinny czech
- black monster cocks
- pale big tits
- indian girlfriend
- big natural boobs
- natural tits teen
- brutal interracial
- british blonde milf
- ball gag
- birthday anal
- loads of cum
- chubby small tits
- casey calvert interracial
- massage parlor blowjob
- clit orgasm
- big black dick
- black rimming
- chubby solo
- jeans porn
- massive cum
- busty handjob
- vintage dp
- asian casting
- braces anal
- shoes masturbation
- black cheerleader
- full movie anal
- jessie rogers anal
- footjob in car
- tiny lesbian
- shop
- ass solo
- amateur anal casting
- white cock
- extreme skinny
- karla kush lesbian
- blonde beauty
- milf lesbian lovers
- redhead granny
- black cock massage
- kacey jordan interracial
- lesbian party
- shaving pussy
- granny tits
- white panties
- balls deep
- dads hot girlfriend
- amateur anal compilation
- pure cfnm
- rough interracial anal
- fat mom
- pov bj
- big boobs anal
- latina daughter
- sweet teen
- elegant anal
- huge black
- first orgasm
- stretching
- honey moons
- naive teen
- night club fuck
- hairy chubby
- real orgasm
- lesbian masturbation
- fake taxi ebony
- ebony creampie
- nicole aniston solo
- cum on legs
- lesbian boots
- busty beach
- lesbian moms
- big booty lesbian
- step brother porn
- black on blonde
- mature solo
- japanese lesbians
- toilet pov
- helpless teens
- ryan keely lesbian
- bbc gloryhole
- dress fuck
- skinny blonde
- female ejaculation
- pumped pussy
- massive creampie
- cumshot party
- big tit asian
- german dildo
- rimjob pov
- daughter anal
- black pissing
- blonde milf interracial
- fisting gangbang
- virgin pussy
- 3d cartoon
- brutal gagging
- pissing teen
- pussy gape
- milf boy
- german cougar
- granny and young
- best handjob
- ebony feet worship
- sex in public
- brazilian bbw
- aleska diamond interracial
- indian aunty bathing
- sleeping girl pussy
- watching my mom
- classic
- sexy blonde
- passionate lesbians
- italian pornstar
- first bbc anal
- interracial pregnant
- british nylon
- lactating lesbians
- big tits mom and son
- pissing pants
- sexy anal
- cinema sex
- julia ann lesbian
- old men gangbang
- russian outdoor
- lesbians anal
- hairy asian solo
- pregnant anal
- japanese car sex
- french interracial
- curious teen
- massive boobs
- caught and fucked
- kay parker
- amateur dildo orgasm
- busty teen amateur
- big booty ebony
- australian lesbians
- brunette mom
- anal couple
- natalia starr lesbian
- james deen anal
- big tits anal pov
- arab amateur
- big tits massage
- big black tits
- tongue blowjob
- wife suck
- russian lesbian teen
- erotic movie
- fake tits solo
- prison lesbians
- i have a wife
- backroom casting anal
- 18 years old casting
- interracial footjob
- japanese facesitting
- creamy pussy
- anal compilation
- blow bang
- remote vibrator
- kissing compilation
- gaping hole
- big cock gangbang
- bbw blowjob
- bi mmf
- asian guy white girl
- tied blonde
- rope bondage
- huge titjob
- pussy pumping
- filipina threesome
- lesbian feet worship
- bbw deepthroat
- calendar casting
- solo milf squirt
- friend watches
- mature head
- first cuckold
- french anal
- amateur anal pov
- alexa grace interracial
- latina deepthroat
- busty dildo ride
- glass dildo
- big ass threesome
- hard gangbang
- asian mature
- japanese kissing
- pegging threesome
- public fuck
- hot blonde
- black on blondes
- european interracial
- chubby mexican
- israeli girl
- cock massage
- squirt threesome
- booty shaking
- lesbian tit sucking
- big tits shower
- german domina
- 18 sex
- big ass indian
- czech lucie
- annabelle lee lesbian
- blonde latex
- cuckold girlfriend
- small tits blonde
- aunty bathing
- bbw teacher
- ebony nurse
- ebony hardcore
- cassidy banks pov
- french beurette
- dildo gag
- japanese double
- amateur white wife
- big cumshot
- japanese femdom
- bridgette b lesbian
- teen anal creampie
- mature panties
- yoga
- wake up and fuck
- fucking
- ebony pussy
- latin milf
- fucking machine squirt
- riding dildo
- sunny leone lesbian
- skinny lesbian
- teen curves
- katie morgan interracial
- extreme insertion
- drunk german
- bbw solo
- dildo and cock
- lucky old man
- whipped women
- fucking the plumber
- tight thai
- casting pov
- fingering squirt
- topless
- chubby mature anal
- mature dominatrix
- extreme insertions
- horny granny
- asian schoolgirl anal
- mom son pov
- black ssbbw
- taboo mother
- redhead compilation
- kayla paige lesbian
- danny d anal
- extreme bondage
- hairy pantyhose
- angelina castro interracial
- chubby pussy
- girls gone wild
- jenaveve jolie lesbian
- hot babe
- sucking nipples
- mexican amateur
- virgin defloration
- asian big tits
- best friends husband
- big butt amateur
- bbw small tits
- femdom whip
- bikini strip
- russian bbw
- shower pov
- mandy muse anal
- watch jerk
- wrestling femdom
- fat ass latina
- little dick
- milf bath
- lesbian spanking
- lesbian lapdance
- blonde orgy
- blonde stripper
- twins anal
- fat guy fuck
- flashing tits
- italian big tits
- bound orgasm
- interracial anal orgy
- italian swingers
- super hairy
- mistress toilet
- stepmom and daughter
- huge tits blonde
- atm ffm
- fat tits
- black booty
- mexican lesbian
- big white cock
- balls
- new sensations
- asian ffm
- lesbians threesome
- kendra james lesbian
- bubble butt teen
- jessica drake anal
- pool orgy
- teen gagging
- teen creampie
- gangbang squirting
- mature lesbian strapon
- armpit sex
- japanese group sex
- teen hitchhiker
- mature joi
- best dp
- mom and teen lesbian
- college interracial
- monster cock
- latina rimjob
- young petite
- strap on anal
- big bouncing tits
- chubby lingerie
- milf fingering
- young webcam
- doggy style anal
- skinny teen dp
- device bondage
- nikki benz anal
- big tits british
- skinny granny
- sex therapy
- shaving her pussy
- casting couch x
- cum eating
- step sister anal
- lesbian nurse
- retro milf
- bbc white milf
- dirty milf
- hot latina threesome
- pantyhose tease
- anal piss
- grandpa fuck
- asian anal pov
- busty asian teen
- fake cumshot
- beauty solo
- drake anal
- tiny ass anal
- anal threesomes
- pornstar anal
- lesbian nuns
- strap-on lesbian
- erotic wrestling
- high heels fetish
- young lesbian
- cum inside
- teen and old
- german hooker
- curvy latina
- mature pussy
- massive black tits
- anal insertions
- wild anal
- hand job compilation
- dap gangbang
- jenna sativa lesbian
- asian orgy
- rough interracial
- lesbian ass fisting
- busty bbc
- bubble ass pov
- shaved head girl
- noelle easton lesbian
- sophie dee interracial
- indian ass
- stepson porn
- amateur selfshot
- brazilian babe
- couple kissing
- cum on pussy
- russian girl solo
- short hair redhead
- solo pornstar
- gaping anal
- girlfriend pov
- lingerie tease
- big ass asian
- bukkake gangbang
- footjob cumshot
- big tits round ass
- big ass
- lesbians massage
- 18 massage
- bbw busty
- showing pussy
- teen punished
- amateur mom
- piss on
- busty natural latina
- lesbian step
- virtual fuck
- tiny japanese
- pussy worship
- indian solo
- blonde office
- anikka albrite lesbian
- hot teen
- big dick
- double teamed teen
- korean anal
- latex strapon
- cam girl
- big tits stockings
- amateur big ass
- pov cumshot
- amateur rimming
- masked gangbang
- pee
- indian facial
- diamond kitty anal
- sensual massage
- big natural tits solo
- handjob lesson
- teen cumshot compilation
- ebony squirting
- first anal audition
- russian redhead
- jerk off femdom
- students
- smoking sex
- wife masturbating
- mature mistress
- bdsm sex machine
- massive facial
- euro milf
- submissive slut
- czech pov
- french amateur
- many cocks
- teen thong
- homemade pegging
- massive cumshot
- amateur swinger orgy
- wanking instructions
- mom masturbating
- mikes apartment
- all over 30
- ebony massage
- morning blowjob
- love creampie
- ebony lesbian strapon
- squirting milf
- old and young piss
- skinny russian
- ffm creampie
- skirt anal
- gymnastic sex
- blond teen
- ass to pussy
- hairy pussy fuck
- asian softcore
- all internal anal
- sexy webcam
- vintage erotic movie
- latex fisting
- beach pick up
- homemade mom
- bbw blonde
- busty asian anal
- shawna lenee pov
- orgasm contractions
- casting couch creampie
- young asian
- ebony daughter
- aidra fox lesbian
- ex girlfriend
- sucking her own tits
- foot fuck
- nasty wife
- dp
- cfnm facesitting
- romi rain interracial
- milf dp
- bondage leather
- teen girlfriend
- classic lesbian
- skirt sex
- cum party
- domina
- loves cum
- fat amateur
- elevator
- dutch teen
- sex in bed
- double cumshot
- very skinny teen
- gorgeous milf
- husband films wife
- anal cream pie
- teen babe
- shiny panties
- wake up blowjob
- 3d porn
- lingerie ass
- college threesome
- blindfolded interracial
- kendra lust milf
- busty hairy
- vintage porn
- shaved mature
- russian lesbians
- french bbw
- thick mature
- monster clit
- blondes anal
- italian dp
- lesbian lovers
- 18 year
- hijab blowjob
- fat guy hot girl
- anissa kate lesbian
- shemale on shemale
- giant dick
- latex slave
- young ebony teen
- fat granny
- hot anal
- british brunette
- pantyhose footjob
- real amateur
- bbc orgasm
- cute japanese girl
- mom squirting
- balls sucking
- ebony wife
- latina pornstar
- big creampie
- hot teacher
- german amateur
- asian teen solo
- french casting
- beautiful lesbians
- ebony bbw interracial
- moms lick teens
- nurse porn
- julia ann blowjob
- blonde fake tits
- bbc pov
- teen compilation
- hairy retro
- panties pulled down
- piss fuck
- pornstar homemade
- stripped naked
- pussy lips
- two girls pov
- asian nerd
- thick blonde
- polish anal
- ebony cougar
- arab black
- son fucks mom
- romi rain pov
- white ghetto
- naughty daughter
- strapon cum lesbian
- babysitter exploited
- girl next door
- sheena shaw anal
- gangbang orgy
- pov porn
- caught by sister
- restrained
- blonde feet
- pee compilation
- big dick anal
- birthday threesome
- adriana chechik lesbian
- german redhead
- foot domination
- jade nile anal
- latina group
- girls watching guy masturbate
- oiled teen
- cute ebony
- girlfriend masturbating
- mature interview
- nicole aniston pov
- kayden kross lesbian
- als scan
- latina babe
- hardcore teen
- bbw titjob
- tickling feet
- arab milf
- dildo pov
- huge tit teen
- amateur interracial threesome
- breast exam
- handjob compilation
- lesbian pov
- parking lot blowjob
- anime uncensored
- fake tits teen
- best compilation
- cute brunette
- interracial lesbian
- sarah vandella interracial
- two guys one girl
- webcam anal
- glasses gloryhole
- british big tits
- big black ass anal
- white dick
- ebony big tits
- ass toy
- busty euro
- interracial party
- tanya tate threesome
- asian black cock
- toilet lesbian
- jayden james threesome
- hot lesbian
- ebony whore
- mexican milf
- masturbating at work
- brutal anal
- amateur whore
- pretty japanese
- french pornstar
- trampling
- busty milf
- lesbian fetish
- old man cum
- busty gloryhole
- medium tits
- wife blowjob
- valentina nappi anal
- brazilian milf anal
- busty mature solo
- french amateur teen
- facial surprise
- old young lesbian
- august ames pov
- cheerleader throat
- japanese cosplay
- dillion harper lesbian
- yurizan beltran pov
- sex shop
- ebony pantyhose
- lesbian fingering
- muslim anal
- watching my mom go black
- big asian tits
- foot fetish solo
- busty german
- busty slave
- amateur interracial
- air stewardess
- babysitter caught
- milf next door
- fight fuck
- bisexual husband
- huge facial
- riley evans anal
- pool fuck
- sister pov
- asian mmf
- latina public
- lesbian cam
- lesbian close up
- dutch couple
- mature double
- sex in water
- oral sex
- bbw fetish
- kitchen mom
- lesbian housewife
- squirt on cock
- black girl casting
- mom threesome
- 12 inch
- estate agent
- hot striptease
- teen latex
- chubby mature
- exxxtra small
- blonde milf big tits
- lesbian locker room
- chanel preston lesbian
- blonde pov
- stepdaughter pov
- eva lovia anal
- janice griffith squirt
- sexy posing
- veronica rodriguez squirt
- my best friend
- sexy indian
- meaty pussy lips
- delivery girl
- mature woman blowjob
- japan blowjob
- hunks
- euro anal
- male strippers
- fast fuck
- juelz ventura anal
- mature pantyhose
- sex for money
- ffm stockings
- teen footjob
- milf handjob
- 18 year old
- girls posing nude
- medical fetish
- lesbian masturbating
- pants fuck
- japanese office sex
- humongous tits
- girlfriends mom
- reality
- gay orgy
- tied handjob
- sara jay solo
- dildo orgasm
- casting milf
- big ass brazilian
- faye runaway anal
- big tits friends mom
- ebony blowjob cum
- stepdad anal
- toy
- toy orgasm
- uk teen
- viv thomas lesbian
- spanking girl
- hot moms
- erotic solo
- outdoor pov
- lesbian police
- mmmf
- public big tits
- black midget
- cartoon porn
- amy brooke interracial
- lesbian old young
- ariana marie anal
- milf fisting
- joanna angel anal
- extra small teen
- naked dancing
- interracial rimming
- european teen
- big pussy
- nude walk
- busty strip
- wake up sex
- gape threesome
- white teen bbc
- squirt fuck
- interracial missionary
- tit bondage
- young black pussy
- bbw slut
- tranny teen
- bent over desk
- cervix
- baby cakes anal
- big tits ebony anal
- female casting
- riley reid pov
- black bbw
- jillian janson anal
- milf threesome
- hot babysitter
- brett rossi lesbian
- milf teach
- gloryhole milf
- funny anal
- milf stepmom
- dirty masseur
- long pussy lips
- huge toy
- self bdsm
- brunette handjob
- teen car
- amateur footjob
- petite girl
- lesbian daughter
- dutch bbw
- thai compilation
- lesbian bath
- rough face fuck
- indonesian amateur
- lela star anal
- hot shemale
- russian young
- mom daughter
- shaving hairy
- filipina blowjob
- latina ffm
- russian teen anal
- milf big boobs
- college sex party
- big tits big ass
- lesbian redhead
- lesbian shower
- lesbian pussy lickin
- double anal compilation
- milf sugar babes
- asian amateur
- huge dick
- night
- squirting solo
- german gang bang
- teen facefuck
- amateur bbc
- brunette lesbian
- webcam fuck
- ebony cheerleader
- tara lynn foxx anal
- latex lesbians
- greek porn
- busty brunette teen
- virgin guy
- cock sucking
- curvy lesbians
- athletic milf
- big tits japan
- horny stepmom
- lose virginity
- mature office
- kiki minaj anal
- footjob compilation
- busty black girl
- close up fuck
- bethany benz anal
- big clit sucking
- india summer mom
- son fuck his mom
- big ass arab
- japanese teen uncensored
- micro bikini
- loose cunt
- solo girl fingering
- strapon pegging
- daughter interracial
- busty blonde teen
- suck off
- tricked into sex
- short hair granny
- live show
- naked dance
- japanese rough
- morgan lees
- escort casting
- all holes filled
- 40 something
- milking machine
- amateur solo
- club sex
- small pussy
- tied fucked
- old man licking pussy
- lesbian anal fisting
- redhead mistress
- wifey handjob
- briana banks lesbian
- teen big cock
- big tit blowjob
- group handjob
- latina dp
- smoking fetish
- lesbian milf seduces
- spanking mom
- 69 lesbian
- anal cream
- strip club sex
- lesbian old and young
- stepsister anal
- lana violet anal
- anal boots
- ebony masturbation
- japanese pee
- goth lesbian
- wife watches husband
- lesbian anal teen
- black pregnant girl
- korean
- foot fetish lesbian
- bbw strip
- submissive cuckold
- russian chubby
- mia malkova anal
- girlfriend cumshot
- lesbian slavegirl
- casting couch anal
- stepsister pov
- lesbian slave
- big tit milf lesbian
- passionate blowjob
- big tits czech
- tiny ebony teen
- german orgy
- lingerie gangbang
- gorgeous solo
- while watching porn
- amateur sextape
- natural tits pov
- gloryhole amateur
- redhead slave
- kendra lust threesome
- lesbian gangbang
- teens dp
- mom masturbation
- busty blonde milf
- best handjob ever
- cum together
- spanish bukkake
- classic black porn
- schoolgirl teacher
- teen girl
- black pussy close up
- mom watching daughter
- kelly divine anal
- cheating housewife
- skinny lesbians
- lesbian blindfold
- solo squirt
- italian pornostar
- beauty anal
- teen audition
- fit mature
- hairy casting
- ebony envy
- drunk mom and son
- pussy insertion
- two girls anal
- asian piss
- blonde solo
- krissy lynn interracial
- fantasy mom
- pantyhose orgasm
- black boots
- big tits tease
- ebony public
- teaching lesbian
- bbw tranny
- india summer interracial
- colombian teen
- nerdy teen
- bukkake orgy
- teen rough anal
- daddy fucks daughter
- strapon party
- africa sexxx
- brooklyn lee anal
- clothed blowjob
- brutal whipping
- gigantic boobs
- your mom tossed my salad
- daughter caught
- sweetheart video
- family group
- mom stuck
- curly
- lara cumkitten
- anissa kate creampie
- teen flashing
- up skirt
- riley reid compilation
- wants you to jerk
- web cam
- deep throat gagging
- street whore
- hot granny
- head bobbers
- old daddy
- granny compilation
- mature masturbation
- white girl asian guy
- foot compilation
- anal fist
- mature boy
- pregnant fuck
- nylon bondage
- las vegas
- amateur pov blowjob
- redhead mature
- nurse solo
- lingerie pov
- rough ffm
- fuck a fan
- japanese slaves
- bbw samantha 38g
- bisexual mmf
- curvy british
- obedient slave
- ebony webcam
- model fuck
- hairy cock
- bbw striptease
- big boobs fuck
- angela white lesbian
- teen ass to mouth
- teen lingerie
- pussy fucking
- bbw glasses
- friends dad
- aletta ocean interracial
- thai pov
- all holes
- exploited college
- jenny hendrix anal
- glasses anal
- stockings blowjob
- interracial gangbang dp
- pov tits
- asian camgirl
- barely legal ebony
- angel rivas anal
- caught masterbating
- tall teen
- old and young couple
- hairy russian
- lara latex anal
- brazilian blonde
- lesbian pee
- public adventures
- big tits german
- ebony lesbian strap on
- japanese gal
- hairy milf solo
- barely legal
- big anal
- young facial
- best deepthroat
- bizarre insertions
- stockings milf
- asian bbc anal
- mature public
- old man maid
- lesbian seduces
- big booty milf
- cum on lips
- naked interview
- solo big tits
- redhead milf anal
- bts anal
- turkish porn
- step sister pov
- 2 girls 1 guy
- redhead deepthroat
- german group
- eat pussy
- amateur homemade
- teen pov anal
- pussy massage
- mommy roleplay
- asian lesbian threesome
- shower anal
- sex for cash
- nerd anal
- shower spy
- chubby lesbian
- sex toys
- cum in mouth swallow
- monster facial
- riley reid facial
- perfect teen tits
- webcam squirting
- pissing compilation
- feet tease
- bbw outdoor
- public flashing
- beautiful teen
- big puffy nipples
- crazy anal
- salad tossing
- jeans ass
- lexington steele anal
- brown
- cuckold sessions
- jerk off instruction
- milf huge tits
- desi lesbian
- mature teen
- make me cum
- blonde mistress
- big booty white girls
- asian masturbation
- big load
- british milf
- shemale joanna
- mind controlled
- japanese titjob
- perky nipples
- street blowjob
- mature black
- lesbian anal licking
- asian cum
- bbw anal
- bbw interracial
- redhead masturbate
- dungeon
- love
- karla kush interracial
- sex slaves
- enhanced tits
- japanese pissing
- mature and young boy
- japanese blowjob
- juicy ass anal
- beach sex
- fucked hard
- black cock anal
- interview
- tiny blonde
- blowjob surprise
- asian pornstars
- shaking orgasm
- balloon fetish
- missionary position
- rocco siffredi teen
- hairy blonde solo
- ebony pov blowjob
- femdom milking
- mature secretary
- hardcore fuck
- hairy blonde
- gf creampie
- bath masturbation
- amateur 18
- jerking off
- blowjob cum swallow
- pussy insertions
- natalia starr anal
- fuck fest
- skinny hairy teen
- pawg anal
- mom fucking son
- backroom milf
- bdsm lesbians
- russian model
- tease and denial
- amateur orgy
- teen huge tits
- pee toilet
- teen sister
- katrina jade interracial
- massage seduction
- glasses solo
- mature slut
- first sex teacher
- lesbian photographer
- christie stevens interracial
- mofos anal
- blackmailed mom
- homemade interracial anal
- milfs in heat
- india summer lesbian
- huge fake tits
- japanese footjob
- smoking fuck
- milf and teen
- evil angel anal
- big tit teen
- bbw domination
- stranded teens
- softcore sex scene
- italian teen
- old man blowjob
- amateur cfnm
- cum covered
- bobbi starr anal
- skinny outdoor
- sexy brunette milf
- fake agent
- sexy teen
- atk girlfriends
- suction cup dildo
- russian teen dp
- latina doggy
- huge natural tits solo
- deepthroat contest
- babysitter threesome
- squirting teen
- dp teen
- pussy lick
- british teen
- pawn shop fuck
- milf wrestling
- mature foot
- porn audition
- grandpas fuck teens
- redhead anal
- amateur black cock
- emily austin interracial
- all internal
- black piss
- bbw ass
- lesbian ass play
- chubby hairy pussy
- amateur schoolgirl
- cfnm mature
- isis love lesbian
- skinny amateur
- extreme bukkake
- teens pov
- sex in library
- sara jay interracial
- hairy cunt
- thai schoolgirl
- hot blowjob
- swallow compilation
- busty cheating wife
- japanese hot
- hot pov
- bbw lingerie
- white on black
- homemade teen
- amateur anal masturbation
- big tit milf solo
- swollen pussy
- old goes young
- blonde teen interracial
- fucking glasses pov
- black and white
- tied and fucked
- emo
- crazy japanese
- chubby babe
- blonde teen casting
- taboo sister
- big ass solo
- amateur bondage sex
- blonde threesome
- strip games
- penis massage
- petite dp
- lesbian catfight
- hairy black
- masturbate together
- porn parody
- interracial gangbang
- x art threesome
- cum inside pussy
- short hair anal
- anal toys solo
- nikki benz blowjob
- granny creampie
- monster boobs
- big ass mature
- german blonde amateur
- her first anal sex
- brazil pov
- busty ffm
- squirt on face
- toilet blowjob
- petite ebony anal
- amateur big booty
- sexy solo
- interracial femdom
- brunette teen anal
- ass tattoo
- fake massage
- german bukkake
- busty latex
- teacher porn
- hitchhiker anal
- interracial anal gape
- teen fingering
- british pornstar
- brutal double
- wank it now
- czech anal casting
- guy sucks tranny
- black girl dildo
- giant tits ebony
- wife shares husband
- latina big ass
- multiple creampie
- jeans strip
- drunk sex
- spanking schoolgirl
- nasty
- wifes first bbc
- big fat ass
- hotel fuck
- party blowjob
- indian wife
- cum bang
- beach fucking
- foot worship lesbian
- mature tits
- russian brunette
- premature ejaculation
- fuck team
- dominant woman
- teen huge cock
- french big boobs
- sexy mom
- first time fuck
- fucking glasses
- outdoor group
- japanese milf beauty
- best creampie
- ebony feet
- solo posing
- birthday gangbang
- bears
- ebony rough anal
- anal oiled
- girlfriend facial
- ebony submissive
- japanese tied
- gloves handjob
- teen squirt
- monster cock amateur
- big cum
- cum explosion
- homemade redhead
- mouth piss
- bbw stripper
- huge tits pov
- face sit
- public sex adventure
- beach tits
- wife threesome
- tied blowjob
- lesbian foursome
- sovereign syre lesbian
- italian milf anal
- casting couch
- rough anal compilation
- stockings mature
- sex therapist
- double anal penetration
- 18 year old ebony
- 18 year old blonde
- strapon guy
- mistress strap on
- hairy pissing
- india summer anal
- braces cum
- amateur granny
- stockings anal
- mia malkova interracial
- big ass interracial
- wife rio
- nurse bondage
- bbw face sitting
- massive tits
- mature milf
- black teen pov
- thai solo
- brunette webcam
- eat cum
- deepthroat queen
- jessie volt anal
- milf bukkake
- voyeur masturbation
- babe ass
- latina pov
- anal finger
- backroom anal
- ebony strip
- car handjob
- jennifer white interracial
- british masturbation
- big boobs teen
- self bondage
- capri anderson lesbian
- latex dress
- ryan conner anal
- booty compilation
- very wet pussy
- immoral live
- back room casting couch
- small blonde
- cum between tits
- evil angel
- aletta ocean solo
- naked run
- amateur couple anal
- public anal fisting
- german outdoor
- rocco siffredi casting
- lesbian interview
- wife pov
- white teen
- anal domination
- big tits daughter
- latina strapon
- hairy hippie
- daughter threesome
- bbc squirting
- tamed teens
- solo porn
- teen creampies
- ass squirt
- amateur pov anal
- short hair mature
- secretary dp
- blonde tranny
- bikini solo
- british slut
- handjob queen
- casting facial
- hot indian
- piss shower
- cowgirl pov
- mature couples
- japanese pantyhose
- big butt orgy
- teen socks
- alina west anal
- mature hairy pussy
- uk milf
- machine squirt
- ebony fishnets
- shower dildo
- puffy nipple
- anal hook
- extreme face fuck
- rough doggy
- pregnant lesbian
- big butt bbw
- massive facials
- rough bbc
- sexy boobs
- first anal casting
- teen cheerleader
- first big black cock
- rocco siffredi anal
- milf pov anal
- masturbating together
- brazilian anal
- sloppy bbc
- keisha grey interracial
- mature massage
- cougar boy
- chinese webcam
- nerd fuck
- cum licking
- mature fake
- riley reid interracial
- huge fake boobs
- ron jeremy vintage
- mature young
- latex mask
- japanese public sex
- twins fuck
- puke throat
- vietnamese teen
- anal toys
- cum swapping compilation
- bbw fuck
- sexy brunette
- standing sex
- handjob facial
- escort girl
- white monster cock
- milf joi
- busty student
- cheerleader anal
- son and mom
- serenity anal
- magic handjob
- kinky anal
- xxx parody
- hard rough sex
- big booty latina
- perfect tits teen
- british bbw
- short haired mature
- group sex
- big tits teacher
- mature bbw solo
- sexy wife
- chubby pornstar
- teen sex slave
- brandi love threesome
- casting interview
- busty vintage
- my sisters hot friend
- stripper gangbang
- down blouse
- anal ride
- ball gagged
- pussy pump
- stripping hairy
- bound and gagged
- lesbian friend
- dp star
- lesbian ass
- samantha rone anal
- wet orgasm
- huge areolas
- blonde secretary
- hairy girl
- big tits latina
- sloppy deep throat
- iranian girl
- bbw fucked hard
- skinny japanese
- vintage compilation
- sweet petite 18
- busty hentai
- bald girl
- cum on face
- hairy bush
- nude contest
- blonde stockings
- slutty mom
- tasha reign anal
- cfnm humiliation
- cuckold dp
- cute indian girl
- ebony tribbing
- hairy mom
- fuck doll
- pissing lesbians
- anal submission
- czech dp
- mature fake tits
- bdsm orgy
- lesbian clit licking
- old woman young boy
- dp squirt
- white pussy
- horse cock
- ashley adams anal
- mom strip
- nudist teen
- maid dp
- strapon deepthroat
- milf lesbian
- exposed in public
- hospital
- amateur blowjob
- amateur casting
- young tiny asian
- big white dick
- young interracial
- webcam deep throat
- lesbian fuck
- foursome couples
- shower big tits
- ashley fires anal
- hairy orgasm
- chubby asian
- british pantyhose
- czech casting milf
- whipping
- girls masturbate together
- teen group sex
- bathroom anal
- blonde teen pov
- italian solo
- barefoot solo
- messy facial compilation
- chubby indian
- stage show
- fat dick
- bus fuck
- sensual anal
- clothed handjob
- anal close up
- hot creampie
- hot mom anal
- milk solo
- horny housewife
- euro
- delivery boy
- couple share
- spandex leggings
- blowjob facial
- milf doctor
- beautiful milf
- dad daughter anal
- brazilian dp
- jayden jaymes creampie
- heels fuck
- japanese old woman
- huge boobs solo
- ebony dildo solo
- white hairy pussy
- femdom pony
- milf compilation
- madelyn monroe anal
- bubble butt anal
- outdoor squirt
- cowgirl
- real virgin
- kissing lesbians
- pregnant bbw
- ebony teen blowjob
- german lesbians
- vibrator in public
- erotic threesome
- hard deep throat
- lesbian ass lick
- chubby huge tits
- abella danger lesbian
- pussy cream
- skinny latina
- pov reverse cowgirl
- alexis texas lesbian
- doggy style pov
- british mature bbw
- wife licks ass
- ebony outdoor
- interracial maid
- petite amateur
- russian creampie
- milf swallow
- stepmom pov
- hot chinese girl
- japanese solo
- sister and brother
- hentai femdom
- dildo masturbation
- bbc face fuck
- latina bbc
- beautiful tits
- mom catches son
- flexible solo
- chinese amateur
- anal car
- wrestling strapon
- bikini big tits
- milf young lesbian
- skinny amateur anal
- alexis texas threesome
- busty casting
- sophie dee anal
- sex machine
- stepmom caught
- maid anal
- mercedes carrera anal
- gonzo porn
- interracial group
- bondage fuck
- tied up anal
- twins kiss
- ebony couple
- big natural tits anal
- shower sex
- adriana chechik pov
- lesbian fitness
- uniform anal
- pov doggy style
- wifes hot friend
- young latina
- big cock deepthroat
- female agent lesbian
- clit pumping
- japanese anal creampie
- two girls gangbang
- interracial mmf
- cougar interracial
- classic milf
- pegging compilation
- homemade anal
- african big ass
- homemade dildo
- dildo blowjob
- multiple creampies
- black nipples
- brazilian foursome
- african masturbation
- french solo
- mature big dildo
- amateur cumshot compilation
- french redhead
- aiden starr lesbian
- solo masturbation
- karmen karma anal
- lesbian beach
- sex
- interracial audition
- delivery guy
- heels
- car fuck
- teen milf lesbian
- ebony anal
- black bubble butt
- high heels
- tanya tate lesbian
- japanese bdsm
- amateur shemale
- interracial oil
- tied bbw
- maid threesome
- married man
- teen schoolgirl
- dirty latina maid
- sex dolls
- asian teen
- alura jenson anal
- japanese hardcore
- latina big tits
- double anal
- tug job
- sleeping anal
- firm tits
- shemale gangbang
- college
- public masturbation
- mom ass
- dad anal
- maddy oreilly interracial
- vegetable insertion
- cuckold creampie eating
- african teen
- ebony footjob
- young porn
- petite porn
- milf solo
- natasha nice lesbian
- teen strip
- infernal restraints
- manuel ferrara anal
- skinny pale
- dap anal
- russian blowjob
- anal dildo solo
- deep anal
- black amateur
- blonde slut
- orgy compilation
- trying anal
- public pussy
- pregnant german
- handjob with glasses
- innocent lesbian
- male slave
- russian whore
- amateur riding
- webcam handjob
- gorgeous ebony
- close up anal
- tongue
- bbw lesbians
- huge juggs
- sucking dildo
- indian slut
- very hairy pussy
- busty hooker
- german threesome
- rubbing pussy
- old couple and teen
- slender
- foot licking
- outdoor bondage
- milf femdom
- shower handjob
- exploited college girls
- street
- adriana chechik interracial
- euro dp
- lesbian fantasy
- french porn
- shemale solo
- stand up fuck
- brooklyn chase anal
- teen tied
- hot friend
- bukkake party
- solo dildo
- bondage sex
- cum swap kiss
- stripper blowjob
- ass to mouth
- busty brazilian
- asshole tongue
- lesbian ballerinas
- french maid anal
- babysitter pov
- shitty anal
- interracial shower
- car creampie
- hairy vanessa
- asian tranny
- ava dalush interracial
- german femdom
- solo girl
- 18 years
- stepmom anal
- black couple white girl
- booty anal
- public striptease
- petite wife
- camping lesbian
- blue hair
- big natural
- beach strip
- couch anal
- best blowjob
- boobs fuck
- big tits strip
- hard machine
- parody anal
- tiny petite
- bedroom sex
- black blonde anal
- chubby threesome
- dirty talking milf
- japanese creampie gangbang
- petite college chick
- mainstream sex
- squirting machine
- lyla storm anal
- plump ass
- caught masturbating
- korean amateur
- tiny teen solo
- teens ffm
- german mmf
- milf nylon
- nipple licking
- anal teen threesome
- just 18
- milf internal
- throat swallow
- panty job
- hard creampie
- virgin teen
- gorgeous
- amateur asian blowjob
- german granny
- birthday fuck
- seduces son
- ass close up
- anal instruction
- crazy lesbian
- cuckold creampie
- czech bbw
- amateur asslick
- webcam squirt
- black booty anal
- amateur couple homemade
- bbc creampie
- shemale fucks girl
- japanese group
- petite brunette
- latina handjob
- solo orgasm
- lesbian milfs
- vintage deepthroat
- dad daughter taboo
- hardcore threesome
- mom and daughter lesbian
- latina teen solo
- latex bbw
- bbw facial
- rough anal gangbang
- sara luvv lesbian
- british lesbians
- femdom pov
- behind the scenes anal
- ebony teens
- arab teen anal
- erotic massage
- audrey bitoni office
- multiple blowjobs
- big tits fisting
- japanese nuru massag
- italian orgy
- maid handjob
- busty german teen
- french blowjob
- bbw teen
- mandingo interracial
- fuck machines
- zafira solo
- tiffany doll interracial
- dirty mom
- big natural tits teen
- mouth fucking
- russian babe
- thai babe
- mom interracial anal
- hairy blonde lesbian
- india summer threesome
- french gangbang
- big brazilian orgy
- boyfriend films
- fat redhead
- indian teacher
- lesbian student
- lesbian milf and teen
- sexy feet
- feet licking
- lesbian orgasm
- mature maid
- lesbian pussy eating
- black big booty
- mature anal fisting
- friends watching
- extreme pussy
- busty tranny
- try teens
- mexican solo
- young casting
- double teamed teens
- kristina rose anal
- asian rough
- hairy granny
- big ass wife
- anal gape compilation
- joi ass
- interracial couple
- fucking mom
- bukkake compilation
- foot job
- dp chubby
- deep pussy
- homemade sex
- lesbian kitchen
- pale interracial
- her first black cock
- latex tied
- bisexual
- big tits french
- redhead massage
- lesbian mom and daughter
- asian cosplay
- curvy webcam
- blindfolded sex
- sex for rent
- cock pump
- muscle milf
- big tits teen anal
- teen bondage
- milf massage
- stockings bondage
- fake cum
- asian double anal
- hard body
- teen bush
- naked ass shaking
- girl masturbating
- webcam anal dildo
- curvy redhead
- hot brunette
- cherie deville lesbian
- lesbian sisters
- big tits office
- penny pax lesbian
- plump blonde
- hairy lesbians
- lisa ann milf
- indian webcam
- lesbian armpits
- doctor cfnm
- begging for cum
- rough anal sex
- shorts
- teen dancing
- tied femdom
- game
- anal queen
- busty blonde solo
- petite 18
- eva lovia solo
- ssbbw ass
- topless beach
- young lesbians
- hardcore squirt
- carter cruise lesbian
- public bus sex
- lesbian bitch
- extreme fuck
- milf anal threesome
- ebony fake tits
- sister creampie
- asian milf
- lesbian ffm
- busty secretary
- big breasts
- london keyes anal
- screw my wife
- sister brother
- fucks fan
- beautiful anal
- amateur big boobs
- whipping extreme
- asian slut
- ebony girlfriend
- goth blowjob
- girlfriend interracial
- deep throat compilation
- short teen
- amber lynn bach mom
- mom and daughter interracial
- bbw bondage
- czech blonde
- sloppy gagging
- nude interview
- cumshot compilations
- skinny latina anal
- lady sonia fuck
- busty blonde cougar
- blonde milf
- ass traffic
- triple penetration
- rough amateur
- classy mature
- mother
- erotic anal
- swallow cum
- pawg interracial anal
- japanese shaved
- wife caught cheating
- loves anal
- hot stepmom
- petite creampie
- pregnant amateur
- latina anal
- blonde shower
- pov oiled
- ebony facial
- black cock
- audition pov
- booty shorts
- blonde interracial anal
- self anal fisting
- ass stretching
- big tits squirt
- katsuni anal
- edging blowjob
- milf pov blowjob
- big black
- star wars xxx
- german latex
- ass massage
- latex lesbian
- milking compilation
- blue angel fisting
- milf anal pov
- teen booty
- ass destruction
- asian teen creampie
- stripper cumshot
- vicki chase lesbian
- milf gangbang
- blondes interracial
- amateur panties
- escort busty
- hardcore pov
- cum on tits
- beautiful wife
- old ebony
- lesbian couple
- japanese slut
- lesbian squirt
- skinny schoolgirl
- fucked on phone
- horny girl
- doggy creampie
- shy blowjob
- guy tied
- riley reid gangbang
- big ass black
- classy milf
- student party
- bbw compilation
- mom seduces
- office orgy
- christie stevens anal
- big tits asian
- lactating breasts
- natural tits anal
- ebony stripper
- mature housewife
- bbc massage
- busty katerina
- redhead feet
- erotic sex
- morning fuck
- teens do porn
- lesbian audition
- thai dp
- sex scene
- 80s busty
- brunette blowjob
- big tits dildo
- chunky mature
- filthy whore
- pee in mouth
- ebony white cock
- big anal dildo
- brutal face fuck
- beautiful amateur
- big cock pov
- rough throat
- sexy girls
- school girl sex
- swimming pool
- black maid
- rico strong interracial
- fat mature
- gym sex
- casting couple
- strapon compilation
- briana banks anal
- japanese chubby
- kinky mom
- amateur blonde
- boobs solo
- milf big black cock
- finger squirt
- amateur public
- double pussy penetration
- ebony teen gangbang
- black blowjob
- femdom muscle
- ava addams pov
- bbw handjob
- petite asian teen
- drunk amateur
- cute asian teen
- facesitting slave
- naked yoga
- portuguese sex
- milf young
- anal creampie eating
- submissive girlfriend
- family fuck
- beach handjob
- lesbian passion
- classic bdsm
- brunette mature
- big pussy creampie
- angela white anal
- mature dancing
- english
- wife watches
- blindfolded gangbang
- amateur cum in mouth
- lesbian big ass
- wifes mom
- teen small tits
- sex wrestling
- bangbus teen
- korean solo
- housewife anal
- asian tits
- blonde massage
- bbw milf
- naked cleaning
- feet handjob
- pantyhose blowjob
- slim milf
- milf seduced
- mature solo masturbation
- big tit teen anal
- german mature anal
- small teen anal
- boots milf
- nicole aniston blowjob
- old young lesbians
- skinny teen pov
- fat booty
- throat fucking
- ebony fisted
- big tits interracial
- vintage big tits
- karla kush anal
- asian pussy spread
- russian blonde anal
- teen machine
- spanish teen
- bar anal
- blonde riding
- russian porn
- coed
- in the vip
- monster cock anal
- very hairy
- squirting compilation
- asian sister
- busty dildo
- dirty ass
- black lesbians
- dirty whore
- syren de mer mom
- anal for money
- mouth fuck
- broke amateur
- begging for anal
- wife first
- first porn casting
- high heels fuck
- gina gerson anal
- petite anal teen
- period sex
- czech babe
- dutch webcam
- amateur cunnilingus
- latin maid
- mature lesbian
- suck balls
- sex doll
- brazzers threesome
- sloppy kissing
- blacked blonde
- creampie closeup
- schoolgirl creampie
- boots porn
- tiny teen anal
- sweetheart lesbian
- super hot
- prinzzess lesbian
- double sided dildo
- hairy babe
- amateur dp
- german whore
- 3d animation
- hairy redhead anal
- public jerk
- virtual blowjob
- teen seduced
- fetish solo
- milf footjob
- japanese shemale
- smoking blowjob
- amateur feet
- czech taxi
- caught masturbation
- big ass interracial anal
- lesbian sex
- insane anal
- solo close up
- cuckold session
- interracial group sex
- cosplay anal
- double pussy
- horny mom
- long dildo
- big tits black
- jerking
- dana dearmond interracial
- ebony anal dildo
- public pov
- sexy luna
- ass hole
- petite bbc
- indian amateur
- wet ebony pussy
- lesbian mom seduce
- old man anal
- blonde tits
- sister sucks brother
- stepmom blowjob
- shiny dress
- squirt massage
- wet panties
- first time dp
- standing fuck
- dont cum
- public webcam
- romantic sex
- office strip
- french mature
- blowjob cumshot
- natural busty teen
- first monster
- ebony anal pov
- fuck my girlfriend
- english milf
- jynx maze blowjob
- busty audition
- milf interracial anal
- forest sex
- white slut
- hottie
- summer dress
- lesbian pussy licking
- first time on camera
- big tit plumper
- teen anal casting
- lola taylor anal
- ebony big booty
- amateur car sex
- waitress anal
- ball licking
- japanese anal uncensored
- young girl older man
- milf for cash
- mature lady
- busty blowjob
- anal creampie casting
- ebony blowjob
- strapon domination
- hardcore compilation
- big saggy
- ebony ass shaking
- cfnm office
- black lesbians eat pussy
- real public
- hairy milf
- big asses
- busty sister
- amateur slut
- kelly star anal
- asian dominatrix
- classic ron jeremy
- red head anal
- asian doggystyle
- asian webcam girl
- mature handjob
- asian stripper
- interracial gang bang
- upskirt tease
- hairy arab
- bound gangbangs
- shaved asian
- upper floor
- teen dildo riding
- 8th street
- lesbian squirting
- mardi gras
- casting big tits
- young teen couple
- mature cougar
- shemale fuck
- two girls deepthroat
- cute dp
- jessica jaymes blowjob
- barely legal lesbian
- elegant milf
- shemale massage
- anal fun
- virtual sex with
- euro threesome
- long dildo in ass
- mom compilation
- indian milf
- lexi belle compilation
- black facial
- amateur wife shared
- caprice lesbian
- husband
- ftv lesbian
- big dildo anal
- hairy spreading
- indian aunty
- turkish teen
- chanel preston pov
- yoga anal
- pussy creampie compilation
- lesbian hot tub
- boat orgy
- tiny ass
- dad fucks daughter
- anal addict
- outdoor dildo
- young mistress
- creampie compilation
- brooklyn chase interracial
- my very first time
- asian bikini
- cock trampling
- dorothy lemay
- latina footjob
- deep throat
- ukrainian
- sleeping brother
- extreme squirting
- party hardcore crazy
- homemade fingering
- huge boobs
- lingerie dp
- ebony ssbbw
- homemade threesome
- chubby teen fuck
- beautiful mom
- abella danger interracial
- ass creampie
- romance
- young blonde
- skinny massage
- ass spreading
- aunt and mom
- amateur colombian
- hot girlfriend
- marley brinx anal
- deauxma lesbian
- hot legs and feet
- extreme deep throat
- tiny anal
- group sex party
- japanese porn
- mature stripping
- fat pussy lips
- anal party
- german swinger party
- pov fantasy
- czech home orgy
- ffm teen
- thai big tits
- fat cuckold
- hotel
- fit ebony
- fucked hard 18
- milf masterbation
- bbw pornstar
- ebony stockings
- teen ass
- ebony gf
- natural boobs
- oiled asians
- spanish amateur
- cfnm cum
- helpless teen
- asian threesome
- ebony teen pov
- nude sport
- girl sucks shemale
- lesbian strapon
- rachel starr threesome
- russian teen lesbian
- pregnant milf
- ebony ass
- backstage
- new anal
- gangbang dp
- bbc handjob
- asian pussy
- double rimjob
- boy fuck milf
- plump mature
- asian anal bbc
- mom catches
- hot sister
- married couple
- after shower
- dick massage
- naked walk
- fantasy
- rough blowjob
- tit wank
- shemale fuck shemale
- fake cock
- spanish threesome
- lesbian schoolgirl
- babes solo
- big bubble butt
- big tits wife
- lesbian jail
- fffm
- black girl masturbate
- money talks
- fake hospital
- interracial pov
- oil tits
- sexy redhead
- lesbian teen threesome
- amateur teen anal
- bbw ffm
- asian squirting
- blanche bradburry anal
- skinny blonde milf
- blowjob race
- pantyhose masturbation
- milf strip
- everything butt
- back room casting
- anal orgasm
- asian teen anal
- huge tits
- anal strapon
- japanese squirt
- sophie dee lesbian
- lexi belle anal
- card game
- asian tied up
- boyfriend
- sauna amateur
- hairy webcam
- day with pornstar
- anal fetish
- busty chubby
- massage girls
- sexy bbw
- fully clothed sex
- outdoor solo
- homemade bondage
- love making
- giant dildo
- lesbian ass worship
- pov anal threesome
- bondage threesome
- extreme hardcore
- asian panties
- interracial amateur anal
- clit piercing
- anal exam
- best doggy
- amateur car blowjob
- gaping
- hard deepthroat
- outdoor amateur
- explicit sex scene
- biggest clit
- hairy outdoor
- milking handjob
- shy asian
- babysitter anal
- teen orgy
- lingerie solo
- rocco casting
- hot and mean lesbian
- high heels solo
- double vaginal
- sisters boyfriend
- cheating teen
- latina masturbating
- pov tit fuck
- husband films
- russian anal teen
- face fuck compilation
- virtual sex
- creamy orgasms
- tattooed blonde
- ebony big boobs
- granny threesome
- gorgeous mature
- latina sex tape
- beautiful webcam
- massage blowjob
- toss salad
- share cock
- bound and fucked
- blindfolded wife
- bouncing boobs
- anal teen massage
- doggystyle compilation
- teen foursome
- sweet sinner
- asian porn
- reality kings teen
- amateur webcam
- pussy fingering
- street anal
- cum in mouth
- japanese creampie
- oral overdose
- schoolgirl facial
- teen pantyhose
- japan mom
- ggg gangbang
- heavily pierced
- milf double
- dirty mature
- son watching mom
- bondage squirt
- beach cabin
- granny anal
- nurse anal
- cum in ass compilation
- eat some ass
- female domination
- spread pussy
- hard tied
- korean teen
- sensual lesbian love
- asian interracial anal
- huge tits teen
- panties tease
- ride a cock
- busty masturbation
- kenna james lesbian
- french hairy mature
- sierra ebony
- dancing
- luna star pov
- nasty slut
- hitachi squirt
- big boobs mom
- blonde joi
- black group
- petite gangbang
- teen 3some
- asian amateur teen
- foot pov
- huge dildo insertion
- french threesome
- dildo doggystyle
- busty latina teen
- italian mature
- lesbian twin
- anilos solo
- vintage teen
- shorty mac
- big tit pov
- japanese school girl
- lesbian anal strapon
- sissy boy
- amateur interracial blowjob
- redhead strapon
- curvy ass
- tiny pussy
- bikini fuck
- fucked panties
- chubby ffm
- nina elle anal
- big butt teen
- fake casting
- perky teen
- tanned anal
- bdsm anal
- mistress joi
- pick up anal
- gangbang slut
- tanned
- swedish
- big tits hairy
- teen blowjob pov
- riley reid lesbian
- big tits secretary
- black cock gangbang
- lesbian 69
- pussy tattoo
- outdoor handjob
- german skinny
- big boob
- flexible sex
- spreading pussy
- huge tit lesbians
- big tits lesbian
- drink piss
- teen pornstar
- lexi belle interracial
- ass to mouth threesome
- front of husband
- round ass
- wife black
- mature anal
- webcam blowjob
- clothed masturbation
- anal fucking
- amateur allure
- latina booty
- phoned while fucked
- young babe
- tit whipping
- kate anal
- ebony creamy
- japanese gagging
- yoga milf
- blonde lesbians
- milf facial
- uk amateur
- chubby gf
- lesbian milf threesome
- blonde pornstar
- aaliyah love lesbian
- mom and son
- gym lesbians
- homemade shower
- busty teen solo
- big tits at work
- arab sex
- asian kitty
- asian huge tits
- blacked interracial
- black hair sex
- teens orgy
- huge black tits
- teen boots
- asian homemade
- thick bbw
- pregnant lactating
- ass job
- lily labeau interracial
- innocent high
- shiny spandex
- white pantyhose
- angell summers anal
- jim slip anal
- extra small
- solo babe
- teen pies
- female agent casting
- black cock slut
- bride gangbang
- pregnant lesbians
- teen toy
- cuckold threesome
- santa claus
- without condom
- big tits gangbang
- shaved head
- busty mistress
- 3 girls
- sandy lesbian
- native american
- mya luanna anal
- tit sucking
- webcam boobs
- small ass anal
- big butt blonde
- cam show
- remy lacroix solo
- rough fuck
- latina girlfriend
- big natural tits milf
- capri cavalli lesbian
- hairy natural
- bbc cuckold
- thai anal
- brutal gangbang
- kiki daire anal
- sleeping son
- lesbian anal sex
- girl scout
- lesbian analingus
- blonde mom
- big tits lesbians
- russian big tits
- my friend's hot mom
- teen anal gangbang
- nurse blowjob
- stormy daniels lesbian
- bonnie rotten squirt
- slut wife
- busty wife
- black dick sucking
- club fuck
- drunk wife
- asian cumshot
- ricki white anal
- showered with cum
- sasha grey interracial
- mom handjob
- gabriella paltrova lesbian
- shemale feet
- dylan ryder threesome
- lesbian lactation
- african hooker
- nuru massage fuck
- rough deepthroat
- denim shorts
- swallow loads of cum
- teen anal compilation
- cum swapping
- busty ebony milf
- petite dildo
- sapphic erotica
- asian feet
- bondage deepthroat
- milf throat
- ebony riding
- kitchen bbw
- amateur bondage
- skinny solo
- behind the scenes blowjob
- pee drinking
- jessica jaymes threesome
- homemade cumshot
- outdoor anal
- handjob cum
- brutal spanking
- cumshot compilation
- japanese teacher gangbang
- wife compilation
- crossdresser fuck
- brunette squirt
- pillow masturbation
- lezdom anal
- busty black teen
- doggy style
- puffy nipples
- girls way
- chyna anal
- creampie
- skinny mature anal
- redhead masturbation
- danish teen
- blacked anal
- latin anal
- homemade sextape
- british handjob
- riley reid bbc
- huge clit
- doctor anal
- huge white cock
- big ass shemale
- teen shower
- hidden
- russian teens
- cute teen
- teen interracial gangbang
- deepthroat gag
- japanese bukkake
- smoking lesbians
- brazilian interracial
- hairy mature redhead
- sara mature
- anal big tits
- interracial gape
- virgin ass
- amateur blowjob swallow
- teen rimjob
- mom and daughter anal
- huge ass bbw
- milk tits
- amateur mmf
- mom daughter threesome
- blonde public
- mark wood anal
- heavy tits
- three lesbians
- two girls suck cock
- fake taxi creampie
- gaping pussy
- babysitter teen
- interracial squirt
- softcore sex
- squirt face
- shy wife
- private casting
- chubby bikini
- busty tattoo
- jynx maze solo
- rough dp
- granny masturbation
- brother pov
- anal dildo gape
- ebony deepthroat
- busty teen anal
- brandi love lesbian
- daughter dad anal
- boat anal
- hairy girlfriend
- bubble bath
- amateur milf blowjob
- czech harem
- gloryhole cumshot
- anal saga
- petite japanese
- perfect teen
- ebony sloppy
- little tits
- improvised toy
- sorority hazing
- blonde pawg
- redhead teen pov
- interracial outdoor
- step sister
- skinny milf
- dirty old man
- pee in ass
- awesome blowjob
- asian anal
- asian kim
- white girl bbc
- amateur babe
- cum multiple times
- dutch anal
- ebony toy
- balls deep creampie
- curvy blonde
- julia ann milf
- teen school
- anal fisting lesbian
- tiny teen interracial
- redhead gangbang
- glamour babe
- mature masterbating
- christmas fuck
- beach teen
- cute amateur
- double dildo
- skin diamond threesome
- mandy muse interracial
- french teen
- big tit redhead milf
- lactating lesbian
- mature outdoor
- teen party
- girlfriend feet
- sleep assault
- dildo deepthroat
- cute gangbang
- mature mom
- kate england anal
- best anal ever
- juliet anderson
- mira sunset anal
- fit milf
- marica hase anal
- asian teen amateur
- sleeping sister
- sexually broken
- group blowjob
- asian audition
- tattooed asian
- brazzers lesbians
- messy creampie
- teen daughter
- impregnate mom
- girlfriend strip
- czech teen
- perky tits
- cute solo
- dick licking
- ebony ass worship
- school sex
- fat pussy
- sensual blowjob
- casual teen sex
- domination wrestling
- japanese cumshot
- lesbian milf teen
- brother and sister sex
- cute bbw
- curly teen
- old man fucks teen
- nipple clamps
- czech lesbians
- mom caught
- shemale fucks female
- group orgy
- little anal
- arab solo
- slave threesome
- boss sex
- big tit lesbians
- watching mom
- teacher anal
- jasmine jae interracial
- diamond foxx
- lady sonia blowjob
- korean blowjob
- double teamed
- asian schoolgirls
- cum kiss
- japanese nurse
- fake taxi big tits
- busty japanese mom
- black slave
- nude mixed wrestling
- huge tits handjob
- brazil anal
- tori black interracial
- redhead big boobs
- freckled milf
- pov fuck
- russian virgin
- fucking machine bondage
- teen girls
- teen panties solo
- latex gloves
- blonde slave
- prison
- big tits masturbating
- lesbian teens
- blonde cougar
- pregnant pov
- japanese masseuse
- mature casting
- amateur group
- ebony student
- fucked hard 18 massage
- anissa kate pov
- asa akira blowjob
- bridgette b anal
- pantyhose solo
- mature hairy blonde
- lesbian bed
- panty stuffing
- punishment
- nun anal
- nude workout
- handcuffed blowjob
- tori black lesbian
- black cum
- toilet piss
- colombian teen anal
- beautiful granny
- pretty face
- young girl old
- monsters of cock
- mom son roleplay
- black cock dp
- mature strapon
- big tits brunette
- lovers
- facial cumshot
- busty pov
- shemales fuck girls
- mom fucks son
- big tit mom
- swallows loads
- anal only
- gagging compilation
- tail plug
- food insertions
- blonde teen anal
- big tit babysitter
- phat ass ebony
- busty gangbang
- jeans anal
- german schoolgirl
- tanned blonde
- lesbian school
- pigtail redhead
- lesbian anal domination
- big tits footjob
- madison ivy anal
- japanese secretary
- homemade anal creampie
- old anal
- mexican anal
- giant anal dildo
- janet mason interracial
- anal creampie gangbang
- hairy latina
- proxy paige anal
- big tit sauna
- eating
- malena morgan lesbian
- nipple sucking
- too big for her
- skinny webcam
- orgy party
- australian milf
- black rough
- spanked and fucked
- ebony rimjob
- fuck my wife
- avluv lesbian
- ffm blowjob
- cum shower
- titty fuck
- black cum swallow
- julia ann interracial
- ecg anal
- handjob threesome
- dirty lesbian
- katie kox interracial
- lingerie sex
- reality kings lesbians
- czech couples
- latina teen pov
- piss humiliation
- samantha bbw
- busty mom
- pale redhead anal
- goth anal
- lesbian stockings
- black cock pov
- cum on
- mom teach sex
- pale redhead
- whipped cream
- ebony fucking machine
- lesbian mommy
- teen double
- hot webcam
- open pussy
- milf seduction
- real anal
- sucking black cock
- japanese big
- creampie party
- oiled massage
- rough fingering
- dirty latina maids
- paddle spanking
- amateur sybian
- lesbian ass licking
- in front of husband
- homemade interracial
- thick anal
- private gold
- european anal
- amateur interracial cuckold
- male domination
- big tits tattoo
- french stockings
- skinny brunette teen
- bbw strap on
- nudist camp
- giving head
- big tits lingerie
- wife outdoor
- daughter masturbating
- foot fetish
- bed bondage
- interracial blonde
- teen webcam
- sister handjob
- hentai game
- amateur bbw threesome
- real wife stories
- squirt in mouth
- hairy armpits
- lesbian seduction
- ass licking milf
- bikini contest
- stockings dildo
- insertion
- fuck for cash
- daddys girl
- ana foxxx lesbian
- teen sex
- casting couch hd
- japanese housewife
- bathtub sex
- long legs anal
- lesbian caught masturbating
- cowboy
- black cock cum
- skin diamond anal
- hot asian
- lesbian piss drink
- my friend hot mom
- perfect ebony
- asian on white
- asshole licking
- jeans fuck
- german tits
- blonde anal pov
- wife foursome
- busty ebony anal
- tiffany doll anal
- curly hair teen
- angry wife
- riley reid deepthroat
- feet femdom
- pussy cumshot
- father daughter sex
- first time casting
- interracial facesitting
- jynx maze threesome
- pussy stretching
- tied to bed and fucked
- tanned milf
- bikini anal
- bus anal
- big ass webcam
- bisexual teen
- darryl hanah interracial
- thai porn
- cucumber anal
- strapon fucks guy
- perfect boobs
- alana evans lesbian
- stepmom and son
- russian teen amateur
- brunnette
- 12 inch cock
- granny stockings
- bbw redhead
- public pickups
- fucking machine
- faye reagan solo
- gloryhole mature
- pierced nipples
- wake up handjob
- throat compilation
- czech couple
- asian bondage
- closeup blowjob
- student anal
- teen handjob
- aidra fox anal
- hypnotized girl
- stripper party
- lesbian cop
- lesbian anal dildo
- cumshots compilation
- kathia nobili blowjob
- daddy pov
- ssbbw mature
- milf maid
- brother fuck sister
- hung boy
- brunette ass
- anal fingering
- redhead threesome
- brandi love milf
- shemale dick
- milf audition
- angelica heart anal
- girl strapon guy
- huge cum
- milf tits
- 69 sex
- lesbian hooker
- fat lesbian
- soldier
- squirting orgasm
- mom femdom
- sleeping girls
- intense orgasm
- eva notty interracial
- french teen anal
- pawg interracial
- sensual lesbian
- mistress handjob
- webcam facial
- redhead milf
- ava devine deepthroat
- sarah shevon anal
- car blowjob
- two girls masturbating
- creamy dildo
- boot worship
- squirting pussy
- lesbian scissoring
- latex dildo
- girl rimming
- hairy creampie
- milf anal gangbang
- photoshoot sex
- cougar gangbang
- blowjob cum in mouth
- while on the phone
- latex corset
- young filipina
- black lover
- best anal
- jerk off challenge
- old men young girls
- hairy teen
- skinny blonde anal
- hillary scott anal
- bathroom fuck
- german bbw
- shemale fuck girl
- masturbation together
- mischa brooks lesbian
- russian solo
- japanese rimming
- romantic anal
- cutie anal
- spandex sex
- hairy big tits
- sucking
- strip game
- wife doggystyle
- tape gagged
- celebrity sex
- girl watching porn
- hot korean girl
- riley steele anal
- asian blowjob pov
- mature anal sex
- fat blonde
- old hooker
- riding pov
- kagney linn karter solo
- ebony babes
- asian foot fetish
- redhead tattoo
- lesbian threesome
- pregnant mature
- two black cocks
- petite blonde teen
- uncensored japanese teen
- first anal scene
- sleeping dad
- big ass compilation
- in the crack
- punk tattoo girl
- ebony casting
- 18 year old anal
- ebony cumshot
- self pee
- tiny 4k
- wife gangbang
- pantyhose fetish
- lesbian toys
- pov deepthroat
- redhead stockings
- young creampie
- gf pov
- pregnant sex
- homemade dp
- cock milking femdom
- oil solo
- multiple orgasms
- teen lara
- august ames interracial
- milf striptease
- milf deep throat
- asa akira compilation
- anal squirt
- swinger foursome
- redhead orgasm
- japanese hairy
- do porn
- big tits japanese
- mature striptease
- extreme toys
- rimming compilation
- ebony lesbian
- black stepdaughter
- wifey cumshot
- amateur blonde teen
- blonde college
- latex boots
- retro porn
- claire robbins anal
- taboo vintage
- black girl blowjob
- amateur pussy eating
- blonde teen solo
- gaping asshole
- amateur pissing
- submissive husband
- nylon solo
- cuckold story
- masturbation encouragement
- solo compilation
- 3some
- extreme rough
- interracial swingers
- chubby british
- ebony natural
- bbc gagging
- dirty blowjob
- polish girl
- office masturbation
- fuck my ass
- canadian teen
- indian hardcore
- amateur cum
- horse riding
- nurse dp
- big ass bbc
- alyssa reece lesbian
- real couples
- hardcore lesbian
- webcam deepthroat
- vacuum tits
- huge tits amateur
- light skin ebony
- amateur pov
- birthday blowjob
- big tits cum
- hungarian
- sensual jane interracial
- british whore
- latex big tits
- nickey huntsman anal
- cute lesbian
- busty japanese wife
- sophia fiore anal
- nerdy asian
- posing nude
- ffm casting
- filthy anal
- caught fucking
- amateur latina
- huge cock anal
- asian teens
- mia malkova threesome
- brother fucks sister
- pointy nipples
- internal creampie
- anal teen angels
- hairy asshole
- mom teaching teens
- small tits dp
- ballerina
- anal fuck
- deepthroat puke
- classic gangbang
- asian monster cock
- redhead teen interracial
- hairy czech
- hairy pee
- aj applegate anal
- moans
- lesbian gym
- gym anal
- submissive anal
- pregnant blonde
- milf bikini
- gape compilation
- lesbian cheerleader
- danish porn
- rainbow socks
- smooth legs
- lesbian boss
- japanese bondage
- 50 plus matures
- shaving hairy pussy
- vintage solo
- rocco teen
- two couples
- bbw dildo
- webcam compilation
- big booty black girl
- liza del sierra anal
- granny pov
- femdom ass
- high heels anal
- daddy daughter
- hentai threesome
- big wet butts
- amateur threesome ffm
- tiny latina
- caught naked
- nipple pump
- homemade sex tape
- huge tits solo
- teen ass licking
- anal creampies
- sauna fuck
- neighbour
- perfect amateur
- softcore movies
- black girlfriend
- cum eating instructions
- cheating wife
- katie morgan lesbian
- step sister fuck
- beach blowjob
- hot latina
- panty handjob
- busty 18
- son pov
- inflatable dildo
- mommy pov
- ass licking threesome
- hairy anal teen
- watching my wife
- homemade double
- bbc anal teen
- dildo creampie
- snow white
- interracial swallow
- allie james interracial
- amateur couple threesome
- step sister porn
- cream pie
- big tits girlfriend
- office fuck
- mature tranny
- ebony masturbating
- milf riding
- old mature
- ffm latex
- female orgasm
- rachel starr handjob
- teasing cock
- hairy teens
- daughters hot friend
- pick up fuck
- mature and young lesbian
- lisa ann threesome
- sleeping daughter
- rough facefuck
- underwater masturbation
- bbc throat
- japanese sex slave
- young threesome
- chubby ass
- milf kitchen
- close up creampie
- black girl white
- amateur missionary
- milf anal
- perfect pussy
- skinny russian teen
- foot in ass
- hairy strip
- lesbian lisa ann
- cfnm secret
- busty asian mom
- kitchen sex
- little caprice solo
- prolapse lick
- dirty talk
- squirting masturbation
- lesbian masseuse
- making porn
- jelly dildo
- best milf ever
- ebony gloryhole
- euro gangbang
- big ass lesbians
- femdom compilation
- sperm
- anal training
- interracial doggystyle
- greek anal
- anita bellini anal
- titty fuck compilation
- amateur sex games
- huge ass anal
- big saggy boobs
- blonde teen creampie
- cathy creampie
- hot blonde teen
- doctor adventures
- lesbian fight
- bbw masturbation
- asian lesbians
- lesbian tribbing
- fat bbw
- blonde pantyhose
- japanese fingering
- japanese foursome
- big tits squirting
- foot in pussy
- private casting x
- talking while fucked
- amateur fuck
- pov titfuck
- samantha rone lesbian
- ebony head
- cum filled pussy
- japanese beauty
- sex tape anal
- puffy nipples teen
- black anal
- latina rough gagging
- lesbian first
- huge dildos
- teen tits
- british couple
- triple blowjob
- suspension bondage
- face slapped
- riley reid solo
- mature aunty
- hotel pov
- hazing girls
- japan big tits
- mom fucks sleeping son
- japanese mature
- chubby tits
- big cocks
- rides dildo
- young ebony
- ebony interracial
- ebony threesome anal
- bisexual orgy
- cum for cover
- butt plug public
- security guard
- blond milf
- small penis
- russian deepthroat
- anal tryout
- lesbian foot
- finger fuck
- sunny leone hardcore
- girl lick ass
- collar
- no hands blowjob
- backroom casting couch anal
- blonde pov blowjob
- redhead daughter
- lesbian wife
- monica santhiago anal
- brazzers oil
- marsha may anal
- interracial anal amateur
- skinny asian anal
- nude wife
- hot brunette fuck
- clothed fucking
- great ass
- public footjob
- lesbian anal gape
- asian mom
- daisy marie lesbian
- lelu love pov
- ebony anal gangbang
- redhead pornstar
- hardcore creampie
- natural tits
- met art
- latina doggystyle
- fake taxi blonde
- bdsm threesome
- latina maid
- beautiful ass
- ffm strapon
- amateur sex tape
- amateur femdom
- lesbian three
- natural breasts
- lesbian pantyhose
- oiled ass
- teen anal gape
- tranny threesome
- jillian janson interracial
- asian ladyboy
- chloe lesbian
- tattoo ebony
- blonde dildo
- extreme punishment
- clothed pissing
- deepthroat gagging
- cute japanese teen
- hunk
- cute ebony teen
- pigtails teen
- asian housewife
- mature heels
- massive cock
- jennifer white lesbian
- sister fuck
- chinese porn
- french ffm
- skinny hairy
- glory hole secrets
- public bondage
- shy amateur
- teen maid
- cum slut
- pale skinny brunette
- spanish anal
- legal anal
- boy handjob
- two cocks
- small cock
- jacuzzi
- mother daughter anal
- nicole aniston anal
- francesca le anal
- young amateur couple
- richelle ryan interracial
- mom creampie
- milf gangbang creampie
- first casting
- bbw wife
- oiled solo
- long dick
- rose monroe interracial
- exotic teen
- twins blowjob
- femdom riding
- best friends girlfriend
- lesbian scissors
- indian babe
- teen riding dildo
- double anal gangbang
- best ass
- natural lesbian
- curvy interracial
- cum
- party slut
- feet solo
- ass to ass
- blindfolded threesome
- slow blowjob
- daddys little girl
- nacho anal
- babe dp
- blonde creampie
- british dildo
- brunette casting
- cousin fuck
- real time bondage
- old young swingers
- latin teen
- interracial deep throat
- huge anal
- amateur maid
- amateur wife blowjob
- college lesbians
- lezdom strapon
- hairy man
- bbw interracial anal
- pure mature
- black strippers
- daddy
- cum drenched
- russian schoolgirl
- slut daughter
- oily massage
- exhibitionist
- brazzers anal
- lou charmelle anal
- italian anal
- uncut dick
- sister facial
- femdom bi
- lesbians eating pussy
- lesbian prostitute
- madison ivy lesbian
- kinky amateur couple
- pov double blowjob
- bdsm blowjob
- tiny young
- busty teen pov
- two grannies
- sara jay teacher
- mature latina
- blonde handjob
- romanian amateur
- muslim sex
- ball sucking
- bbc asian anal
- wife squirt
- agent anal
- mature seduces
- masked blowjob
- ebony babe
- boat
- behind the scenes sex
- amazing orgasm
- ffm strap on
- boyfriends dad
- huge boobs anal
- japanese sucking
- assjob
- singapore girl
- interracial blowjob
- nina hartley lesbian
- german goo
- amateur swinger
- busty shemale
- gloryhole swallowing
- wifey world
- big ass latina
- first time lesbian sex
- bbc double anal
- sara jay threesome
- interracial dp
- bbw fisting
- boobs sucking
- legal teen
- german mature threesome
- bound milf
- deep throat swallow
- naughty office
- japanese uniform
- alt girl
- slippery massage
- german slave
- desi webcam
- doctor sex
- bbw mmf
- french ebony anal
- ass destroyed
- tanlines
- housewives gone black
- euro foursome
- ebony shower
- huge tits anal
- small asian
- lesbian cheerleaders
- kitty anal
- tiny teen huge cock
- husband watches wife
- fisting lesbians
- czech brunette
- vicky chase anal
- deep throat balls
- jade jantzen anal
- eva notty threesome
- rocco siffredi threesome
- mean lesbian
- naughty america
- tightest pussy
- step mom anal
- cum swap
- redhead mom
- dripping wet pussy
- daughter taboo
- underwater sex
- lick man ass
- lesbian seduces girl
- big tits pantyhose
- little caprice pov
- latin mom
- petite threesome
- petite solo
- dorm sex
- giant black cock
- pantyhose sex
- taxi sex
- bisexual vintage
- erect nipples
- hairy lesbian
- lesbian worship
- cunnilingus
- japanese old and young
- japanese kinky
- shaved teen
- japanese handjob
- mature mom and son
- walking naked
- big ass bbw
- busty tied
- webcam porn
- asian mistress
- gay men
- tits compilation
- mulatto
- fake interview
- dp anal
- sloppy deepthroat
- extreme fisting
- schoolgirl gangbang
- ass fisting
- chanel preston threesome
- fitness babes anal
- milf and boy
- samantha saint anal
- new slut
- jennifer white creampie
- 3way
- kaylee hilton interracial
- panty tease
- milf orgasm
- sister caught
- japanese big boobs
- chinese black
- czech casting
- latex
- teen interracial creampie
- babe anal
- hairy masturbate
- bbw mature
- swinger orgy
- pov throat
- boobs kissing
- pregnant cuckold
- young small tits
- kitchen quickie
- milf black cock
- chloe foster lesbian
- muscle lesbian
- double anal teen
- anal slave
- asian interracial
- pov blowjob facial
- stripper anal
- dirty lesbians
- cum in mouth pov
- redhead sister
- homemade porn
- bangbros teen
- webcam couple
- teen carolina
- shemale teen
- dirty slut
- machine orgasm
- outdoor fingering
- dirty panties
- czech girl
- teen braces
- blonde girlfriend
- busty italian
- sexy ebony
- flat chested lesbian
- bathroom masturbation
- ex gf
- japanese panties
- enormous tits
- bbw brunette
- orgasm face
- drunk college girl
- thai girls wild
- busty pornstar
- big tits milf pov
- asian big black cock
- mom pov anal
- lesbian strap on threesome
- glasses porn
- horny sister
- double anal fisting
- petite teen pov
- ebony double
- hand job
- asian secretary
- sexy ass
- lots of cum
- latina bbw blowjob
- cfnm blowjob
- japanese teen
- hairy legs
- amateur mom blowjob
- sophie dee pov
- black couple
- mature nudist
- elegant
- panty fuck
- scissoring
- hungarian anal
- lesbian maids
- lesbian virgin
- sex art
- reverse gangbang pov
- erotica x
- doggy style compilation
- asian milf pov
- stockings porn
- innocent teen
- college teens
- bisexual boys
- moms teach
- brazilian mature
- anal for cash
- tantra massage
- busty latina pov
- drunk amateur blonde
- briana banks milf
- big ass ebony
- phat ass white girl
- slut rachael
- asian dildo
- throat fucked
- shower lesbians
- daughter dad blowjob
- hot thai girl
- huge natural
- japanese nurse handjob
- milf boss
- asian asshole
- hairy bbw
- best interracial
- footjob blowjob
- two milfs
- cock tease
- lesbian cosplay
- adriana chechik gangbang
- african porn
- shiny pantyhose
- orgy pov
- anal toy insertion
- white ass
- ffm pov
- exotic amateur
- asian interracial dp
- asian friend
- celebrity
- naked girls
- british mom
- brazzers milf
- black lesbian strap on
- milf gape
- emo teen
- milf masturbation
- big tit massage
- gigantic cock
- prolapse
- amateur boobs
- pony play
- teen picked up
- lesbian stepdaughter
- extreme throatfuck
- humping masturbation
- busty mature redhead
- babysitter interracial
- she loves anal
- amateur student
- female agent
- money talks fuck
- interracial massage
- library masturbation
- amateur ebony teen
- close up pussy
- amateur ass to mouth
- nylon feet
- moaning fuck
- suck daddy
- hentai blowjob
- hentai tentacle
- real doll
- panty pissing
- covered in cum
- mature blonde
- annie cruz femdom
- black deepthroat
- pov stockings
- latina schoolgirl
- brazilian mom
- condom sex
- ian scott anal
- first blowjob
- cum eating cuckold
- bbw pov
- mature shemale
- roxy raye anal
- cheating wives
- interracial hardcore
- college couple
- redhead schoolgirl
- bbw boobs
- redhead webcam
- girl strap on guy
- bbc pounding
- swinging tits
- german housewife
- italian milf
- beach creampie
- ebony bikini
- busty ebony white
- teen solo girl dildo
- lesbian foot domination
- latex femdom
- hot solo
- chubby girl
- lesbian best friends
- teen mmf
- tonights girlfriend
- anal destruction
- danny mountains
- real mom and daughter
- hairy anal
- asian cheating
- anal casting couch
- big wet ass
- his own cum
- french milf
- japanese interracial
- asian girlfriend
- webcam milf
- shemale cum
- flashing
- ddf busty
- sexy blowjob
- charlotte stokely lesbian
- nudist
- interracial rimjob
- spit roasted
- stepmom shower
- fuck machine
- black milf
- mmf
- twins
- mature big tits
- redhead interracial
- big bouncing boobs
- polish teen
- flashing boobs
- bubble butt pov
- milf doggystyle
- best tits ever
- extreme
- public agent
- toilet slave
- ruined handjob
- ass licking lesbians
- big tits threesome
- interracial wife
- hairy wife
- old man fuck teen
- blonde interracial dp
- french dp
- selfshot masturbation
- young old
- bootylicious ebony
- russian group
- mistress t
- pussy juice
- gym fuck
- first threesome
- german pantyhose
- dana vespoli lesbian
- hairy shower
- x-art threesome
- moaning solo
- while husband
- best lesbian
- chinese gay
- latina compilation
- petite teen
- lesbian teen
- redhead michelle
- asian masterbating
- chubby latina anal
- nicole aniston interracial
- beach fuck
- czech big tits
- bbc big tits
- lesbian show
- ginger teen
- car jerk
- 69 teen
- anal enema
- dildo compilation
- cameron canada anal
- nudity
- british solo
- anal beads
- stocking solo
- milf teaching teen
- dildo cum
- redhead dildo
- sex games
- lesbian girlfriends
- college lesbian
- lesbian massage seduction
- amateur creampie
- fingering orgasm
- sloppy anal
- gyno fuck
- tape bondage
- doggystyle creampie
- jada stevens interracial
- creampie pussy
- blonde teen
- changes panties
- my friends hot mom
- lesbian car
- french mom anal
- pussy licking compilation
- silicon tits
- bobbi starr bondage
- cross dresser
- bikini lesbians
- shaved creampie
- czech mega swingers
- swingers orgy
- black girl dp
- cum control
- wife and stranger
- asian amateur couple
- big tits mmf
- cum in public
- anal cuckold
- reality kings
- table dance
- ass fuck squirt
- lesbian teen strapon
- teen anal dildo
- homemade creampie
- backseat fuck
- australian teen
- stepsister handjob
- cuckold stories
- schoolgirl handjob
- gang bang creampie
- oral compilation
- teen caught
- asian gangbang
- lesbian double dildo
- brutal
- huge tits threesome
- pawg milf
- lesbian experience
- real gangbang
- cuckold interracial
- lesbian gloves
- trimmed
- mature sally
- amateur strip dance
- cuban ass
- indian masturbating
- asian blowbang
- skinny bbc
- drunk milf
- hairy panties
- caught watching porn
- brazil
- japanese matures
- teen dildo
- big butt mom
- amateur car
- office blowjob
- dildo suck
- tiny cock
- petite latina teen
- glasses facial
- russian homemade
- pregnant ebony
- holly west anal
- mistress anal
- leather mistress
- lesbian wedding
- shaved asian teen
- short hair big tits
- bathroom dildo
- lesbian leather
- interracial orgy
- teen gape
- lesbian piss drinking
- car fingering
- milf rimjob
- dani daniels lesbian
- gilf anal
- dirty doctor
- czech tits
- reverse cowgirl pov
- massive tits anal
- brunette anal
- russian teen threesome
- brunette interracial
- blindfolded surprise
- sport
- school anal
- anal big ass
- lusty grandmas
- long cock
- life selector
- german old and young
- family threesome
- lisa ann solo
- bbw big tits solo
- forest masturbation
- skinny masturbation
- ariel redhead
- lipstick blowjob
- bubble butt latina
- nessa devil anal
- pale chubby
- rico strong anal
- maid blowjob
- anal quickie
- gag
- face fucked
- femdom blowjob
- stepmom kitchen
- homemade ass to mouth
- brunette solo
- huge squirt
- monster black cock
- hairy amateur lesbians
- lesbian pussy
- cheating milf
- pornstar dp
- homemade doggystyle
- huge teen tits
- monster ass
- doctor interracial
- teamskeet compilation
- homemade milf
- japanese slave
- asian nurse
- milf in boots
- swedish interracial
- cum face
- courtney cummz pov
- piss enema
- asian gloryhole
- table
- rough threesome
- krissy lynn lesbian
- chubby black
- french pornstars
- muscle babe
- indian pornstar
- taboo brother and sister
- mature bbc
- arab girl
- latina milf anal
- brunette dp
- pantyhose squirt
- shemale fuck guy
- asian schoolgirl
- swallow salon
- colombian anal
- standing
- celebrity blowjob
- caught by mom
- christmas anal
- lesbian doggystyle
- vibrator squirt
- bisexual femdom
- pool anal
- stepmom porn
- latina gf
- school uniform anal
- flexible lesbian
- humiliation pov
- veronica avluv lesbian
- bbw giant tits
- vanessa lane anal
- old and young dp
- christy mack anal
- pregnant black
- little teen
- amateur party
- biggest boobs
- young libertines
- skinny redhead anal
- street blowjobs
- japan milf
- mature nl
- tarra white anal
- skinny anal
- masturbating in public
- lesbian punishment
- pantyhose lesbians
- anal sex
- lesbian roommate
- anal gangbang
- pantyhose high heels
- extreme blowjob
- short haired milf
- first double penetration
- cute milf
- pov huge tits
- german amateur gangbang
- latina gloryhole
- japanese bbw
- breast licking
- audition
- strap on
- boob exam
- huge cumshots
- kim kardashian sex tape
- fake taxi
- pov facial
- the real workout
- amateur teen threesome
- old cock
- young stud
- ebony maid
- gloryhole surprise
- husband share
- reality kings anal
- hot secretary
- all natural
- mom go black
- standing doggy
- young black girl
- monster anal
- gangbang facial
- kaylani lei anal
- big tits redhead
- asian milf anal
- skirt tease
- glory hole
- step mom and daughter
- latex skirt
- lesbian club
- tied machine
- asian squirt
- zoe britton lesbian
- public sex show
- amber rayne anal
- double anal interracial
- squirting threesome
- hitachi insertion
- aussie lesbian
- blonde amateur anal
- teen humiliation
- sexy
- mom pov
- stoya anal
- big strapon
- fake tits
- deep throat puke
- british wife
- milf seduce
- beach boobs
- shemale blowjob
- blonde mature solo
- monster dick
- ass cam
- outdoor quickie
- danny d threesome
- massage anal
- please fuck my wife
- ball busting
- lesbian pick up
- bar sex
- large cock
- amateur squirt
- skinny masturbate
- japanese bath sex
- lesbian car sex
- pierced pussy
- latex threesome
- schoolgirl fisting
- ebony booty
- bbw bbc
- lap dance fuck
- french mature anal
- glory hole anal
- jessie volt interracial
- black casting
- lesbian stepsisters
- granny lesbian
- bbw masturbating
- revenge anal
- serbian porn
- sauna sex
- lesbian schoolgirls
- asian virgin
- her first dp
- long toes
- polish amateur
- female masturbation
- big and small lesbian
- nympho teen
- barely legal anal
- sex fight
- sucking two cocks
- pussy close up
- male masturbation
- pierced tits
- surprise threesome
- french whore
- beauty
- talked into sex
- mr pov
- small girl big cock
- interracial glory hole
- cuckold big tits
- amateur milf pov
- step mom lessons
- britney amber anal
- sex while on phone
- foursome porn
- cock ninja
- skinny asian teen
- woman strapon man
- ass fuck
- redhead bbc
- pornstar pov
- czech gangbang
- skinny ladyboy
- dripping creampie
- japanese mom
- casey calvert bdsm
- rough lesbian sex
- nubiles hardcore
- cammille austin
- latina casting
- amateur titfuck
- girls do porn
- asian sybian
- asian hooker
- taylor vixen lesbian
- romanian
- mouth creampie
- sister fucks brother
- rim job
- solo fisting
- dp orgasm
- pussy whipping
- teen group
- young shemale
- sarah vandella lesbian
- big tits riding
- asian tattoo
- cum on glasses
- tiny dp
- gina gerson solo
- bbc orgy
- small cock blowjob
- big butt ebony
- lesbian foot sex
- handjob pov big tits
- interracial gagging
- tranny fucks girl
- daughter pov
- bikini shower
- big boobs handjob
- wet anal
- cum addict
- webcam sex
- chubby asian teen
- pov cum in mouth
- mom fuck
- girls out west lesbian
- strong orgasm
- stockings threesome
- milf interracial gangbang
- redhead interracial anal
- lesbian neighbor
- couple caught
- big clit lesbian
- wet latina pussy
- spy cam
- nina elle pov
- french anal gangbang
- young pov
- ebony dance
- strap on mistress
- cock compilation
- screaming anal
- natasha nice interracial
- amateur couples
- young teens
- massage sex
- mask
- creampie threesome
- lesbian twin sisters
- wife shared with friend
- latex mistress
- sex lesson
- dirty anal
- strap on mom
- big tits natural
- shemale big tits
- gushing pussy
- big ass pov
- chubby big tits
- puffy pussy
- desi masturbation
- teen slut
- jeans pissing
- big melons
- asian double
- janice griffith pov
- mainstream movie sex
- juicy black
- wet and messy
- swapping partners
- brazilian threesome
- blonde blowjob
- asian girlfriend blowjob
- hotel amateur
- two milfs one
- interracial facial
- watching porn
- tori black anal
- 18 yo
- old young threesome
- moms bang teens
- quick fuck
- chubby interracial
- interracial compilation
- biggest gangbang
- ebony ffm
- french big tits
- aiden ashley lesbian
- chubby blonde
- ebony office
- arab teen
- brazilian porn
- exploited teens
- fat ebony
- mom and stepson
- pool sex
- indian sex
- tongue in ass
- huge black booty
- bbw latina anal
- asa akira threesome
- asian pov blowjob
- white milf
- big boobs solo
- big ass teen
- interracial anal gangbang
- black shemale
- milf orgy
- bbw massage
- tori black pov
- krissy lynn pov
- petite milf
- black prostitute
- german anal
- milf young girl
- megan salinas lesbian
- wet pussy solo
- ebony finger herself
- big booty anal
- hard fuck
- blonde interracial gangbang
- submissive milf
- girlfriend handjob
- petite brunette teen
- black monster tits
- kiss
- hot wife
- teen slave
- fishnet anal
- asian double penetration
- asian whore
- mercedes carrera lesbian
- busty german amateur
- asian anal sex
- couples swap
- teen pussy
- british milf anal
- machine hairy
- bbc deep
- huge tits latina
- ass fucking
- short hair blowjob
- son creampie mom
- office sex
- bus sex
- black girl gangbang
- blackmailed sister
- lesbian trib
- cum whore
- redhead facial
- babysitter
- blonde bikini
- mofos pov
- mormon girls
- food sex
- hate fuck
- massive squirt
- brunette wife
- panty sniffing
- hardcore anal
- granny and girl
- beach interracial
- small tits
- lesbian skirt
- lesbian compilation
- brazilian teen
- anal foursome teen
- live webcam
- playboy plus
- panties fuck
- double creampie
- strapon joi
- busty japan
- husband threesome
- teen spanking
- brazilian orgy
- doctor handjob
- sex and submission
- huge tits gangbang
- riley reid threesome
- mom big tits
- teen first time
- prolapse licking
- oil titjob
- milf creampie
- mompov anal
- japanese nudist
- muslim ass
- my wifes hot friend
- sloppy throat
- london keyes pov
- pigtails
- pornstars orgy
- lesbian dildo
- anal ffm
- bondage blowjob
- big tits sister
- fake taxi teen
- lesbian babysitter
- three girls blowjob
- natural juggs
- self toe sucking
- uk slut
- amsterdam prostitute
- alexa nicole anal
- bubble butt milf
- chubby redhead
- spanish mature
- julia ann office
- gina gerson threesome
- oiled lesbian
- asian rimming
- pantyhose vintage
- cute pov
- busty squirt
- pool blowjob
- romanian anal
- phoenix marie dp
- pierced clit
- pawg teen
- bbw gf
- tattooed milf
- orgy retro
- ebony mistress
- russian cuckold
- japanese boots
- latina masturbation
- japanese oil massage
- creampie gang
- british amateurs
- chubby slut
- wet pussy
- huge tits bbw
- round ass anal
- bathroom sex
- nina hartley classic
- interracial piss
- lesbian tennis
- make him cum
- phoenix marie lesbian
- wife swapping
- cheating latina
- bang van
- body paint fuck
- peep show
- nicole aniston lesbian
- ebony anal threesome
- thai teens
- amateur first
- big tits indian
- white girl and bbc
- cute teen blowjob
- huge saggy boobs
- boss anal
- tattoo pov
- veronica avluv squirt
- public anal sex
- alexis texas anal
- german interracial
- bisexual party
- small boobs
- amateur dildo
- lesbian stripper
- slave interracial
- milf workout
- tiny asian
- extreme throat fuck
- brazilian gangbang
- amateur bukkake
- innocent
- young brunette
- korean lesbian
- massage japanese
- interracial anal compilation
- brazilian milf
- roleplay mom
- boat sex
- lesbian kissing intense
- teens anal
- japanese feet
- beautiful pussy
- black handjob
- asian deepthroat
- lesbian lust
- interracial school
- fuck compilation
- rocco gangbang
- arab blowjob
- japan wife
- natural big tits
- hijab anal
- czech pornstar
- spitting girls
- sunglasses
- cytheria squirt
- teen feet
- asian stockings
- penis pump
- tag team
- busty schoolgirl
- lesbian ass eating
- slim busty
- mom and son sex
- interracial squirting
- mature teacher
- old latina
- pin up
- black on white
- bouncing tits
- big ass amateur
- claudia marie anal
- australian amateur
- slutty teen
- german amateur anal
- belladonna anal
- cum shot
- lesbian outdoor
- japanese orgy
- teen big ass
- tattooed ebony
- monster curves
- saggy tits teen
- drunk gangbang
- gloryhole fuck
- latina stockings
- big tits beach
- lesbian strap
- straight
- wife pays
- foot slave
- bbw threesome
- ladyboy anal
- boots fetish
- alexis fawx anal
- homemade doggy
- lesbians fingering
- big tit latina
- huge tits milf
- panties solo
- strap on lesbian
- hairy teen masturbation
- mature huge tits
- anal cum
- blonde glasses
- amateur sex party
- fake taxi anal
- exploited college girl
- big boob lesbians
- interracial pickups
- home made
- milf cum in mouth
- dildo wife
- dick sucking
- interracial deepthroat
- lesbian hairy pussy
- husband watch
- latina massage
- nylons
- japan threesome
- big butt
- silk panties
- beata undine anal
- mom blowjob son
- deep throat dildo
- couple seduce
- double blowjob pov
- granny outdoor
- webcam strip
- brotha lovers
- amateur facial
- vintage anal
- hot mom
- busty lesbian
- latina interracial anal
- mom blowjob
- feet pov
- big tits pov
- piper perri pov
- fake agent uk
- zoey monroe anal
- arab hijab
- tight teen anal
- cunnilingus orgasm
- mom joi
- massage threesome
- amateur big dick
- pale teen
- mature anal pov
- latina cam
- fatty anal
- creampie gangbang
- skinny mature
- beautiful blonde
- riding cock
- lesbian rimming
- amateur slave
- redhead blowjob
- mud sex
- smoking teen
- filipina teen
- flexible teen
- huge cock
- homemade pov
- sexy handjob
- suck my dick
- ghost fuck
- hairy black pussy
- mature whore
- tattooed
- anal riding
- ball kicking
- busty latina
- deep penetration
- kieran lee
- mouthful
- milf deepthroat
- teen pounded
- british interracial
- asian bbw
- voluptuous milf
- pissed on
- pussy fisting
- secretary stockings
- black stepdad
- latina beach
- german mature blonde
- big tit lesbian
- shower voyeur
- big ass brunette
- cheerleader orgy
- casting dp
- black vintage
- sex teacher
- close up porn
- long hair sex
- mom and son pov
- young redhead
- anal punishment
- teen masturbate
- one lucky guy
- russian mom
- webcam girl anal
- huge tits ebony bbw
- mature orgy
- chubby outdoor
- cum on hair
- ruined orgasm handjob
- licking orgasm
- missionary orgasm
- british lesbian
- sucking tits
- skinny brunette
- my wifes friend
- lesbian dream
- redhead handjob
- condom
- fucking machine orgasm
- hairy stockings
- teen punishment
- big ass latina anal
- asa akira anal
- aunt and nephew
- brunette stockings
- interracial vacation
- car interracial
- homemade face fuck
- nikki sexx anal
- wide open pussy
- petite indian
- spanish milf
- fffm anal
- busty teacher
- japanese stewardess
- rocco siffredi pov
- katie cummings sister
- interracial creampie
- big tit blonde
- black clit
- bbw cuckold
- nacho vidal anal
- blowjob compilation
- forest lesbian
- caught sucking
- black dildo
- amateur lesbian
- deepthroat compilation
- toilet pissing
- hungarian milf
- piss in mouth
- make you cum
- shemale pov
- high heel insertion
- jacky joy interracial
- german milf
- german solo
- amazing handjob
- hardcore gangbang
- amateur stepmom
- interracial big ass
- tied up teen
- otk spanking
- big tit wife
- fa kings
- huge bbw
- young black
- black on black
- korean bbc
- bisexual threesome
- lesbian mother
- skinny granny anal
- brazilian shemale
- tattoo porn
- arab wife
- asian massage
- skinny stockings
- hairy ebony masturbation
- sex party
- school girl porn
- mature fingering
- lesbian friends
- busty college
- mature hooker
- chubby teen amateur
- drunk anal
- johnny sins threesome
- anal fucking machine
- hot jav
- blonde babysitter
- flexible
- drunk orgy
- boobs anal
- femdom whipping
- italian lesbian
- first time video
- teacher blowjob
- lace panties
- femdom gangbang
- anal overdose
- ass to mouth compilation
- milf mistress
- french milf anal
- bride anal
- over 40 handjobs
- big tits pornstar
- japanese threesome
- passionate
- jerk off encouragement
- german pornstar
- big tits mom
- pissing in mouth
- standing doggystyle
- stockings teen
- latina black cock
- teen seduces
- casey calvert lesbian
- young gay
- cum on big tits
- ffm mature
- german teen
- blonde big tits
- teen mistress
- japanese fuck
- chinese bbc
- ebony interracial anal
- hairy lingerie
- romanian teen
- lesbian anal toys
- japanese casting
- young old anal
- czech teacher
- shaving
- finger his ass
- public blowjob
- chinese interracial
- czech mom
- dancing bear
- lesbian asshole
- big booty lesbians
- jessie anal
- black compilation
- 40 something mag
- hairy threesome
- big squirt
- hardcore lesbians
- teen secretary
- piss party
- lactating tits
- anal sex compilation
- nylon worship
- gf deepthroat
- asian couple
- romi rain anal
- latex solo
- backyard
- perfect ass solo
- ebony schoolgirl
- deepthroat slave
- european lesbian
- anal lesson
- lesbian gymnast
- hairy ebony pussy
- angel wicky anal
- strip
- old lesbian
- amateur anal fisting
- young bbc
- mature double anal
- teen big natural tits
- amateur bdsm
- femdom fisting
- black cock teen
- slim teen
- asian toy
- czech casting anal
- huge natural tits anal
- joi tits
- teen fucked hard
- euro lesbian
- ffm femdom
- lollipop
- big mature
- huge tits lesbians
- metal bondage
- japanese big tits
- japanese double penetration
- piss gangbang
- spandex anal
- mistress kara
- interracial anal blonde
- cuckold fantasy
- dorm orgy
- indian compilation
- mom natasha
- small tits solo
- huge tit lesbian
- paris sweets
- tasha reign pov
- dp compilation
- ffm interracial
- thick latina
- old man young
- mature dirty talk
- mature nylon
- pregnant casting
- amateur lesbians
- ssbbw fucking
- ffm handjob
- cum share
- schoolgirls orgy
- busty milf threesome
- mature black cock
- bridgette b interracial
- real sex
- lesbian julia ann
- hard doggy
- public japanese
- teen outdoor
- pussy in public
- pov missionary
- mature wife interracial
- sexy lingerie
- busty goth
- solo strip
- arab beauty
- teen boobs
- office milf
- feet threesome
- sister seduction
- beautiful blowjob
- bachelorette fuck
- big tits mature
- hard throat fuck
- asian hardcore
- shemale cumshot
- spanked and fingered
- caprice solo
- bbw pantyhose
- nataly gold anal
- gran canaria
- night club orgy
- cherry pimps
- young boys old women
- teen caught masturbating
- milf hardcore
- mother daughter fuck
- slut sister
- double penetration compilation
- amazing blowjob
- lesbian boobs
- skinny feet
- apple booty
- sybian blowjob
- sybian anal
- public nude
- big cock blowjob
- japanese mature uncensored
- asian big cock
- cum drinking
- stripper sex
- intense masturbation
- homemade cuckold
- teen asshole
- ass cum
- heels solo
- shemale boots
- abigail mac interracial
- japanese gangbang
- latina riding
- sex with stephanie
- japanese fetish
- big tits nurse
- fingering herself
- busty pregnant milf
- french lesbian
- golden shower piss
- married woman
- schoolgirl dp
- backroom casting couch
- latina blowjob
- no panties
- secretary anal
- face sitting
- homemade masturbation
- granny sally
- boyfriend watches
- milf rough
- skinny teen anal
- teen interracial anal
- solo girls
- mature threesome
- masturbation instruction
- slow handjob
- big wet asses
- asian deep throat
- hentai uncensored
- asian cuckold
- babe interracial
- asian bdsm
- japanese black
- interracial cumshot
- two girls
- stop time and fuck
- britney amber pov
- babysitters
- bitch stop
- mom helps
- french babe
- fat couple
- big booty white girl
- muscle girl
- short haired ebony
- cock licking
- anal toy
- thai mature
- fingering hairy
- creampie gang bang
- fisting compilation
- stepdaughter porn
- great handjob
- tranny creampie
- beautiful feet
- skinny blonde teen
- thai fuck
- try anal
- young solo
- amateur stockings
- mommy young
- avluv anal
- big ass facesitting
- busty ebony
- actress sex
- petite asian
- british granny
- cum fast
- lesbian experiment
- rough gangbang
- latin lesbian
- amateur gang bang
- two girls suck
- asian footjob
- stockings dp
- slim mature
- socks solo
- nuru fuck
- naughty sister
- strap on threesome
- thai shemale
- beautiful thai
- japanese webcam
- wake up fuck
- lesbian office sex
- perfect gonzo
- nasty mom
- cfnm femdom
- kendra lust pov
- filipina hooker
- russian compilation
- sheila marie anal
- milf pantyhose
- sex show
- cute webcam
- busty milf dp
- lesbian asslick
- bbw public
- maddy oreilly lesbian
- strap on femdom
- caught spying
- casting for money
- outdoor creampie
- japanese huge tits
- bobbi starr interracial
- smoking milf
- cum swallow compilation
- lesbian ass fingering
- massage fuck
- amateur swallow
- brand new amateurs
- shemale bondage
- sex at work
- non nude
- bree daniels lesbian
- 69 position
- ebony facesitting
- ebony model
- anal speculum
- lick her asshole
- petite interracial
- outdoor threesome
- fake boobs
- shaved pussy
- sexy asian
- softcore interracial
- rio hot wife
- mom lesson
- japanese av
- food fetish
- redhead teen
- redhead joi
- daughter father
- exotic girl
- sunny leone solo
- perfect milf
- latina secretary
- fat teen
- cum on belly
- terry nova anal
- orgasm compilation
- busty webcam
- interracial anal threesome
- amateur spanking
- orgasm girls
- homemade hardcore
- ebony milf anal
- ddf solo
- jayden cole lesbian
- hailey young anal
- teacher threesome
- at work amateur
- tall blonde
- interracial booty
- socks
- sloppy face fuck
- sex mex
- car flashing
- smoking mistress
- greek amateur
- italian porn
- young colombian
- brunette pov
- older lesbian
- lesbian slumber party
- lesbian step sisters
- pickup fuck
- british porn
- russian teen
- amazing ass
- cum in mouth blowjob
- watch me masturbate
- shemale dildo
- milf lingerie
- best blowjob ever
- ass fingering
- fingering compilation
- amateur wife interracial
- black ass
- atk girlfriend
- big tits glasses
- fake boobs solo
- webcam cutie
- thai lesbian
- japanese stockings
- milf secretary
- petite squirt
- office gangbang
- redhead swallow
- big ass redhead
- double facial
- ariella ferrera threesome
- brunette teen
- lesbian workout
- vaginal creampie
- cheating
- lesbian movie
- blonde casting
- granny blowjob
- hairy pussy masturbation
- big tits doctor
- blonde asian
- mom seduce
- big tits mexican
- anal licking
- masked
- russian asian
- bisexual cuckold
- cute asian
- milf foot
- early in the morning
- chubby mature solo
- dominant women
- small dick blowjob
- beach solo
- busty thai
- uncensored anal
- ass fucked
- amateur ass
- old young anal
- amateur riding dildo
- milk boobs
- fat old man
- teen lesbian orgy
- pornstar orgy
- milf lesbian seduction
- african anal
- amateur lingerie
- latina mom
- amazing teen
- lesbian dp
- thai hooker
- brunette teen solo
- cuckold strapon
- hairy ebony solo
- cfnm
- mature compilation
- swallow squirt
- bondage fisting
- great tits
- big black dildo
- multiple cum
- panties masturbation
- big tits dp
- pigtail teen
- japanese tease
- redhead cam
- lesbian first time
- outdoor stockings
- short hair mom
- deep throat teen
- passionate sex
- japanese facial
- mom and teen
- kayla carrera anal
- bdsm ebony
- balls massage
- milk squirting tits
- japanese mistress
- brunette porn
- aaliyah love interracial
- amateur girlfriend
- webcam at work
- lesbian dominatrix
- hairy fuck
- old and young group
- mature shower
- big butts
- ass tease
- gonzo anal
- petite black
- cameron teen
- chelsea charms
- russian group sex
- gangbang teen
- russian teen couple
- japanese anal
- erotic creampie
- 3d hentai
- amateur compilation
- fucking machines
- mom next door
- japanese massage fuck
- shemale and girl
- foursome dp
- asian teen pov
- black cock asian
- gia dimarco lesbian
- hairy mature
- asses in public
- chunky latina
- pov sex
- anal dildo riding
- mature blonde anal
- dad fuck daughter
- adorable teen
- big boobs milk
- blonde milf solo
- shemale mistress
- pov masturbation
- sleeping asian
- old and young
- wet and pissy
- nude yoga
- naked gymnast
- jelena jensen hardcore
- sandra latina
- big tits foursome
- strapon cum
- dance fuck
- lesbian bdsm
- amateur bbw
- interracial handjob
- car bj
- fake tits milf
- rough lesbian
- nice ass
- british blowjob
- group piss
- sexy lingerie fuck
- vannah sterling interracial
- bbw orgy
- speculum
- aletta ocean pov
- granny and teen lesbian
- lesbian webcam
- blowjob contest
- milf teacher
- anal cum swap
- amateur teen couple
- latin mature
- old man threesome
- sensual sex
- fucks guy
- czech swinger
- black lesbian
- college girl
- japan pantyhose
- upskirt fuck
- alexis adams pov
- naked wrestling
- dirty talking mom
- glamour
- stockings creampie
- casting couch interracial
- miami beach
- latina amateur
- morgan lee anal
- emily addison lesbian
- teasing
- big breast
- fully clothed pissing
- dominatrix strapon
- short hair interracial
- cum on boobs
- mom caught masturbating
- legal porno
- czech solo
- big boobs asian
- old man and young girl
- tribbing
- pissing anal
- slim ebony
- cum on small tits
- petite compilation
- pakistani porn
- rough compilation
- interracial big tits
- alone masturbating
- blonde gloryhole
- ebony bath
- extreme anal fisting
- bbw huge tits
- first interracial
- bathroom handjob
- chunky blonde
- black step
- library anal
- chubby dildo
- mature couple seduce
- webcam teen anal
- blonde emo
- french foursome
- transgender
- schoolgirl pov
- ebony cam
- facials compilation
- big tit redhead
- bbw feet
- face dildo
- tied to chair
- slut mom
- beach threesome
- slow motion blowjob
- family swingers
- exotic woman
- jayna oso anal
- asian babe
- bikini teen
- lesbian date
- hairy ass
- tall
- ebony teen anal
- virgin first time
- latina cuckold
- rough anal
- busty massage
- granny fingering
- glory hole fuck
- chubby stockings
- busty doctor
- cum gangbang
- solo pussy play
- mason moore anal
- webcam show
- blonde small tits
- brunette milf
- persian porn
- czech milf
- sex in the dark
- extreme tattoo
- heels anal
- gang bang
- babe creampie
- vacation sex
- milf pornstar
- abbie cat anal
- francesca le lesbian
- babe pov
- orgasm control
- private home video
- wrapped bondage
- boss wife
- teen anal
- sweet anal
- black masturbation
- cute teen anal
- lesbian orgy
- bottle in pussy
- sandra romain anal
- dana dearmond anal
- latina tits
- hotel room
- homemade anal sex
- cute blonde
- german fetish
- lesbians 69
- latex nurse
- pissing in ass
- ava devine interracial
- oil ass
- bikini model
- blonde german milf
- club seventeen
- thai teen anal
- drunk threesome
- sexy outfit
- mom son
- mistress facesitting
- milf caught
- teens interracial
- color hair
- sleeping sex
- best facial
- stepmom handjob
- facial compilation
- german mom
- stockings gangbang
- cum in her mouth
- anal instructions
- fat dildo
- chubby college
- asians anal
- bonnie rotten squirting
- two girls blowjob
- first date fuck
- lesbian training
- anal creampie
- exhibitionist public
- cbt mistress
- best friends lesbian
- gilf interracial
- wife seduce
- stripping
- ass and feet
- virgin boy
- mom sucks
- strap on lesbians
- milf punished
- milf over 40
- indian blowjob
- glasses pov
- dripping pussy
- femdom spanking
- australian solo
- femdom sex
- amateur threesome
- cartoon sex
- latina milf
- slut wife gangbang
- how to eat pussy
- group squirt
- mature footjob
- cherie deville anal
- czech orgy
- mature anal threesome
- teen skirt
- ebony beauty
- naughty teen
- busty stepmom
- lily labeau anal
- rough lesbian strapon
- mom porn
- wife fisting
- scarlet red lesbian
- slave creampie
- brett rossi solo
- busty cam
- lingerie anal
- nubiles lesbian
- sex tape celebrity
- indian threesome
- brazilian squirting
- real amateur couple
- big tit
- busty redhead
- squirt orgy
- asian big
- horny lesbian
- milf teaches
- real wife
- anal orgy
- lesbian scissor
- huge toys
- step mom lesbian
- busty granny
- busty interracial
- toon porn
- daughter fucks dad
- goldie ortiz
- ebony pov anal
- lesbian anal play
- shoes
- busty mom and son
- ramon anal
- latex suit
- horny lesbians
- lesbian facesitting
- lexi belle handjob
- redhead lesbians
- slapping tits
- shared
- giant boobs
- teen doggystyle
- busty short hair
- kitchen fuck
- banana anal
- bbc anal gangbang
- amateur anal dildo
- asian guy
- tattoo solo
- ebony pussy solo
- 8th street latina
- housewife
- phat pussy
- horny women
- latex milf
- cfnm teen
- japanese grannies
- japanese squirting
- cream pie gangbang
- monroe solo
- muscle porn
- alexis texas blowjob
- asian strip
- student sex
- cum hungry
- teen fuck
- lucky b
- thai amateur
- chinese solo
- bangbus latina
- thick ass
- jenna ross lesbian
- dildo deep throat
- diamond jackson interracial
- masked wife
- flat chested mature
- pussy licking
- bbc threesome
- porn casting
- tits cumshot
- cock hero
- hard missionary
- piss orgy
- big black booty
- teen gf
- veruca james anal
- black on asian anal
- tied up
- jennifer white anal
- best milf
- pregnant mom
- big black cock
- busty blonde pov
- fucked from behind
- bbw big booty
- german masturbation
- brutal fuck
- mature foursome
- russian lesbian
- desperate amateurs
- czech porn
- small tits mature
- seduced by cougar
- leather
- anal facial
- teen whore
- interracial cum swallow
- amateur teen blowjob
- teen couple
- eve angel lesbian
- swinger club
- pegging
- small anal
- blue eyes
- curvy milf
- amateur doggy style
- hairy brunette
- over 30
- russian milf anal
- milk
- skinny black teen
- adriana chechik anal
- femdom party
- indian pov
- doggy pov
- lesbian cuckold
- submissive cuckolds
- hard fisting
- busty french
- ass cheeks
- fat ass anal
- blonde teacher
- vr porn
- hairy teen pussy
- anal doggy
- bdsm sex
- amateur natural tits
- punk
- creamy pussy fuck
- big booty wife
- redhead bush
- interracial cum
- amateur pegging
- young bbw
- wild party girls
- cfnm handjob
- close up cum
- exotic anal
- teens love huge cocks
- cum again
- caress
- long anal dildo
- rubbing
- pornstar fucks fan
- foot joi
- mistress caning
- teen blowbang
- three black cocks
- old and young lesbians
- breast whipping
- daughter seduces
- japanese masturbation
- big white ass
- stockings solo
- pool threesome
- legs up
- japan cosplay
- hairy pussy solo
- pale redhead teen
- eva lovia lesbian
- extreme interracial
- nasty teen
- atk hairy
- missionary sex
- casting threesome
- hot french milf
- barely legal asian
- giant cock
- brunette threesome
- lez cuties
- richelle ryan pov
- redhead solo
- german swinger
- teen fidelity
- russian amateur teen
- celebrities
- wet blowjob
- love anal
- old milf
- ffm anal teens
- mature dp
- sleeping mom
- chubby girlfriend
- hentai
- busty solo
- petite masturbation
- chubby gangbang
- first porn
- stranded teen
- creampie collection
- lover
- tongue kissing
- step dad and daughter
- big cock
- master costello
- submissive blowjob
- sex game
- webcam orgasm
- young girl old man
- cory chase anal
- busty natural teen
- sperm cocktail
- small teen big cock
- masturbation compilation
- beautiful
- nude dance
- panty insertion
- tight asshole
- oil overload
- short hair amateur
- busty mature
- bbw doggystyle
- raven black interracial
- french teacher
- bbw slave
- gagging
- lesbian erotic massage
- amsterdam hooker
- lesbian foreplay
- morning masturbation
- julia ann solo
- trimmed pussy
- double handjob
- chubby teen
- stepmom threesome
- step sister blowjob
- next door amateur
- lesbian trio
- monster cock ramon
- sleepy
- black mom
- short hair porn
- her first lesbian
- share my wife
- blonde sister
- pussy eating close up
- anal big cock
- homemade lesbian
- yoga lesbians
- milf bbc anal
- young teen
- ebony pov
- skinny brunette anal
- japanese pornstar
- cum on feet
- latina sister
- voluptuous mom
- japanese tits
- nudist beach sex
- chinese lesbian
- mature interracial anal
- big tits ebony
- wife shared
- fat porn
- daddy blowjob
- couple swap
- girlfriend shared
- deep creampie
- homemade mature
- french group
- nude girls
- 18th birthday
- brett rossi anal
- black pussy
- redhead glasses
- submissive teen
- lesbian watersports
- asian masturbating
- jennifer white gangbang
- nika noire lesbian
- black cock blowjob
- huge ebony tits
- french interracial anal
- cock cage
- amateur cougar
- wife tied
- sisters threesome
- ana foxxx anal
- black pantyhose
- indian anal
- face squirting
- teen panties
- japanese gyno
- hd pov
- sister tricked
- japan teen
- wifes friend
- pussy squirt
- lesbian foot worship
- jada stevens anal
- classic pornstars
- nina hartley interracial
- ebony teacher
- strap attackers
- nikki benz interracial
- cfnm cumshot
- oil orgy
- femdom foot
- tiny asian teen
- small saggy
- 60 plus
- car masturbation
- butt plug
- pretty feet
- mea melone anal
- granny pussy
- first time amateur
- round tits
- extreme anal
- sex ed
- latex leggings
- amateur cuckold
- calendar audition
- pregnant wife
- brazilian teen anal
- jerk off
- sinn sage lesbian
- squirt orgasm
- granny fuck
- busty redhead teen
- foot worship
- first double
- milf gym
- homemade femdom
- tiny milf
- black booty shake
- grandpa fuck teen
- milf pool
- snake girl
- domination porn
- lesbian nurses
- lap dance sex
- foot
- amateur fisting
- blonde masturbation
- maserati lesbian
- teen and old man
- cheating anal
- pussy orgasm
- mackenzee pierce interracial
- jada fire blowjob
- monster fake tits
- first gangbang
- chair fuck
- czech casting mature
- phone blowjob
- sandwiched
- gloryhole cum
- college sex
- latina ass
- casting anal
- double cum
- fisting orgy
- lex steele interracial
- flexible asian
- interracial lesbian strapon
- brazilian anal black
- av idol
- dads friend
- sex outside
- petite lesbian
- czech massage
- masturbation at work
- gangbang creampies
- bbw stockings
- cheating blonde
- german blonde milf
- chubby wife
- black pov
- young compilation
- old granny
- lisa ann blowjob
- glory hole handjob
- penetration
- amateur gf
- busty brunette
- wired pussy
- big dildo
- chubby masturbation
- cash interracial
- french slut
- japanese orgasm
- nudism
- tight teen
- jizz
- amateur panties anal
- spanish porn
- spreading
- huge bbc
- huge tit bbw
- homemade deepthroat
- first dp
- hog tied
- atk natural
- massive dildo
- booty call
- teen anal orgy
- voluptuous solo
- gloryhole swallow
- solo teen
- white creampie
- pov blowjob
- desi girl
- amateur strip
- cherie deville solo
- nude wrestling
- black and asian
- tight ass
- shaved thai
- cum in hair
- small tits teen
- asian and black
- bound tits
- couple threesome
- ava addams mom
- real hooker
- cum in eye
- 18 only girls
- face slapping
- big ass dp
- hairy teen bush
- big tits bra
- rough sex
- young chubby
- bbc squirt
- cute young
- bdsm slave
- big tits blowjob
- tushy anal
- mom and teen lick
- lets try anal
- long black dick
- cuckold joi
- dirty gangbang
- whipped cream anal
- valentines day
- ass posing
- lesbian gyno
- hairy armpit
- evil anal
- ebony solo
- nipple ring
- shy lesbian
- cheating wife interracial
- skinny teens
- leggings ass
- german swingers
- pornstars anal
- college amateur
- femdom cuckold
- big tit solo
- valentina nappi pov
- granny facial
- fitness milf
- solo fingering
- homemade threesome mmf
- mom daughter lesbian
- laura teen
- sister blows brother
- pov doggystyle
- asian joi
- enormous cock
- college teen
- british babe
- diamond foxxx anal
- oral creampie compilation
- blindfold threesome
- phone sex
- redhead cuckold
- ryan ryans lesbian
- behind the scenes fuck
- anal sex casting
- deep dildo
- wife sucking
- ffm milf
- erotic scene
- public strip
- mature mother
- blonde squirt
- latina threesome
- strapon dp
- shower masturbation
- photographer fucks
- pov swallow
- tied to bed
- amateur facesitting
- asian interracial gangbang
- chinese foot
- horny daughter
- old young gangbang
- phat booty
- 80s pornstars
- fake taxi redhead
- lesbian stocking
- boobs licking
- ebony dp
- mature anal gangbang
- short hair milf
- home orgy
- asian bj
- teen hooker
- girlfriend creampie
- interracial bdsm
- teens love anal
- sissy slave
- milf big ass
- ebony slut
- stripper fuck
- tits licking
- standing anal
- british mature
- nude dancing
- ebony handjob
- two big black cocks
- big ass white girl
- lexi belle threesome
- dorm party
- nasty lesbians
- latina porn
- asian lesbian
- fitness anal
- alex chance lesbian
- blue angel anal
- latin cuckold
- black anal sex
- ebony rimming
- pissing in public
- missionary anal
- sasha rose anal
- tattoo milf
- sexy costume
- small tit lesbian
- black pussy licking
- girl on girl
- phat ass latina
- sara jay lesbian
- sugar bbw
- bbc compilation
- hard doggystyle
- dildo dp
- natural busty
- caprice anal
- big tits teen
- femdom handjob
- prostitute blowjob
- amateur double
- anal threesome ffm
- big fake boobs
- young gangbang
- chubby shemale
- german pov
- dutch amateur
- jasmine black anal
- japanese wife
- dark nipples
- nikki delano anal
- hot redhead
- bondage tickling
- pregnant creampie
- amateur strapon
- tattooed anal
- latex anal
- valentina paradis
- animation
- strip tease
- uncensored japanese
- day with a pornstar
- sperma gangbang
- german prostitute
- dance strip
- asian masterbation
- spandex fuck
- throat fuck compilation
- chubby granny
- british teen amateur
- cock rubbing
- anal machine
- blowbang
- indian gf
- tied anal
- family strokes
- milf picked up
- black amateur couple
- ebony webcam solo
- ebony masterbation
- granny masturbating
- shemale fucks guy
- intense orgasms
- phoenix marie anal
- 90s porn
- first black cock
- syren de mer anal
- vagina
- curvy wife
- extreme brutal
- retro anal
- petite hairy
- thick mom
- outdoor masturbation
- anal creampie compilation
- retro lesbians
- first bbc
- young blonde teen
- redhead wife
- thick ass anal
- extreme facial
- mature doggystyle
- milf foursome
- czech anal
- gf anal
- pussy cum
- remy lacroix anal
- amateur foursome
- mandingo anal
- vintage movies
- anal fisting
- massive natural tits
- wetting panties
- bondage gangbang
- busty russian
- abella danger anal
- daughters friend
- bbw housewife
- american porn
- skinny milf anal
- first time porn
- richelle ryan anal
- ebony glasses
- big tits outdoor
- pounded hard
- mature short hair
- small tits milf
- rimming black ass
- tickle bondage
- first big cock
- gay interracial
- mature hardcore
- audition creampie
- horny teen
- cum in ass
- ass dildoing
- german blonde
- street sex
- asian amatuer
- fuck buddy
- alice march anal
- anal bondage
- anissa kate anal
- skinny fist
- bbw pawg
- girl pee
- hotel anal
- thick booty
- big tit mature
- ftv public
- blonde latina
- anal stretching
- big tit ebony
- curly hair girl
- latina facial
- dog fart
- mature couple
- tight shorts
- bus
- peeping shower
- amateur drunk mature
- skinny anal teen
- mixed wrestling femdom
- japanese doggy
- oral creampie swallow
- curvy asian
- big black anal
- petite ebony
- pantyhose strapon
- anilos masturbation
- pantyhose boots
- huge tits fuck
- double penetration
- inside pussy
- cute russian
- teen joi
- we live together lesbian
- edging handjob
- first deepthroat
- ava devine lesbian
- foot handjob
- teen boy
- french masturbation
- cute teen pov
- webcam riding
- jack napier interracial
- hot bbw
- taboo anal
- jasmine jae anal
- clothed lesbian
- webcam stockings
- gymnast
- pretty ebony
- bbw nurse
- big boobs dildo
- dildo ride
- huge breasts
- big butt latina
- tall brunette
- curvy mature
- cum on pantyhose
- dp fanatics
- portuguese anal
- french brunette
- big ass ebony anal
- asian masseuse
- asian car sex
- teen double penetration
- homemade facial compilation
- lesbian seduced
- standing masturbation
- footjob socks
- anal feet
- x art
- anal solo
- train sex
- condom blowjob
- pissing on cock
- cum tits compilation
- black babe
- hard spanked
- mom boy
- taxi anal
- creamy fuck
- new pornstar
- hope howell anal
- ass eating
- reality porn
- shy teen
- bbc stockings
- blonde stepmom
- busty bukkake
- cuckold hubby
- german mature lesbians
- french marina
- censored
- dp orgy
- black ass worship
- big tits bukkake
- teen riding
- veronica avluv squirting
- its too big
- drunk mature
- ebony fingering
- little caprice threesome
- private anal
- gloryhole gangbang
- cuckold teen
- ebony dildo
- italian interracial
- panty fetish
- double fisting
- dirty talk milf
- schoolgirl uniform
- lezdom bondage
- big tit bbw
- toe sucking
- anorexic teen
- big cock dp
- bbw anal threesome
- ftv girls
- gloryhole facial
- family sex
- family anal
- turkish amateur
- bdsm party
- indian interracial
- sexy black girl
- valerie de winter
- caroline de jaie
- rayveness anal
- gangbang casting
- hungarian teen
- monster dildo anal
- sensual lesbians
- sitting
- spandex lesbian
- lesbian strapon domination
- mom teaching
- big tits curvy asses
- gorgeous anal
- milf mmf
- kinky teen
- mature teen lesbian
- pov deep throat
- busty dp
- japan slave
- abigail mac lesbian
- euro interracial
- vibrator
- homemade compilation
- ir gangbang
- kagney linn karter dp
- glamour lesbians
- mistress fuck
- cosplay babes
- latina milf pov
- interracial double penetration
- police
- blowbang bukkake
- busty japanese milf
- striptease
- lesbian bar
- ryan conner interracial
- leya falcon interracial
- britney amber lesbian
- busty anal
- spanish gangbang
- mature bondage
- couch blowjob
- deepthroat gangbang
- big ass milf
- british amateur wife
- glasses big tits
- miniskirt porn
- redhead teen anal
- first anal quest
- huge booty
- tia cyrus interracial
- live cam
- wife fuck
- hardcore anal gangbang
- webcam solo
- anal rose
- chinese milf
- cheating girlfriend
- pov fucking
- bachelorette party fuck
- public humiliation
- nurse femdom
- young sister
- balls licking
- thai slut
- avluv squirt
- chubby mom
- horny mature
- alektra blue lesbian
- teen massage
- russian blonde
- naughty step sister
- teen lesbian anal
- share boyfriend
- best tits
- asian ass
- nude female wrestling
- interracial strapon
- sensual threesome
- submissive lesbian
- curvy solo
- tape tied
- big tit milf
- latex domination
- thai milf
- porn movie
- french orgy
- anissa kate gangbang
- amateur mature
- skinny teen strip
- very tight pussy
- cum blast
- horny japanese
- big ass maid
- bbw creampie
- amateur wife
- finger fucking
- tranny anal
- pregnant latina
- anal movie
- gaping ass
- latina throat
- angela white pov
- swapping wives
- brazilian wax
- lesbian pissing
- girls kissing girls
- hotel sex
- big mature tits
- hegre art
- goth teen
- busty orgy
- amateur ebony webcam
- milf masturbating
- naughty wife
- horny milf
- latex fetish
- amwf blonde
- cum on hairy pussy
- blowjob audition
- bbc gangbang
- backroom casting
- extreme anal gangbang
- jerkoff instruction
- flashing in public
- milf ass
- hard lesbian
- casting teen
- big tits granny
- sucking strapon
- reality pov
- glory hole cum
- property sex
- cum on tongue
- petite teens
- stockings tease
- german hardcore
- mature car
- gloryhole secrets
- ava addams anal
- messy anal
- slave blowjob
- public lesbian
- bikini blowjob
- nylon foot
- massage girl
- mad sex party
- first time blowjob
- amateur doggystyle
- strap-on guy
- public quickie
- hairy compilation
- mature glasses
- anal fisting lesbians
- submissive asian
- solo anal dildo
- fresh teen
- teen strapon
- over 40
- mature slave
- amateur masturbation
- caught jerking off
- spanish big tits
- japanese cheating
- sister sucking brother
- creampie swap
- russian threesome
- young cam
- interracial bbc
- hairy ebony
- teen brutal
- busty nun
- mature bikini
- mature interracial
- keisha grey lesbian
- anal cumshot
- marie mccray lesbian
- legs spread wide
- handjob cumshot
- first porn video
- bikini beach
- ivana fuckalot
- black ebony solo
- jerking off watching
- black stockings solo
- thai anal creampie
- chubby german
- sister blowjob
- changing clothes
- webcam tits
- german porn
- ass shaking
- lesbian teacher
- femdom fuck
- pov ass
- veronica avluv gangbang
- exotic solo
- czech redhead
- joi femdom
- redhead rough
- busty czech teen
- milf glasses
- ebony tits
- teen gang
- backroom casting couch creampie
- huge tits mature
- petite latina
- chubby brunette
- glory hole swallow
- bbc ebony
- tattooed german
- lesbian foot fetish
- fat milf
- meaty pussy
- teen double anal
- woodman anal
- german amateur couple
- hard sex
- mom interracial
- cum swallowing
- monster tits
- ebony police
- amateur cumshot
- bbw girlfriend
- ebony squirt
- skinny black pussy
- petite ebony teen
- mature swingers
- japan tits
- fake tits anal
- beautiful latina
- black man white woman
- mommy
- beautiful pov
- riding big dildo
- schoolgirl interracial
- busty glasses
- fat cock
- landing strip
- thai pussy
- seduce young
- petite college
- tattoo bbw
- blonde cam
- footjob threesome
- for the first time
- casting blowjob
- filipina masturbation
- lesbian anal fingering
- busty shower
- czech streets anal
- interracial anal
- tied fuck
- penny pax anal
- horny amateur
- white wife
- toilet anal
- anal dildo ride
- femdom threesome
- pov asian big tits
- lesbian pornstar
- blonde cheerleader
- rubber bondage
- amateur latina teen
- ebony classic
- lesbian nun
- teen gloryhole
- blonde gilf
- old teen
- teen model
- brandi love interracial
- black and white lesbians
- fucked and bound
- gay threesome
- amateur anal creampie
- squirting mature
- tiny ebony
- mutual masturbation
- ballerina sex
- stunning teen
- milf teen
- slow motion cumshot
- girlfriend compilation
- skinny young
- squirt drinking
- destiny latina
- slim anal
- lesbian feet licking
- asian guy interracial
- milf public
- milf feet
- toilet sex
- mia malkova solo
- sex on stage
- czech hooker
- big black butt
- jynx maze anal
- slender teen
- japanese amateur
- teens compilation
- teen pov blowjob
- hard whipping
- cute blowjob
- hardcore bdsm
- watch porn
- ass play
- mature and young
- japanese riding
- olivia de treville
- lesbian blowjob
- wife and sister
- shy teen casting
- boys fuck matures
- lesbian granny teen
- perfect blonde
- lesbians masturbating
- braces blowjob
- japanese babe
- tattooed teen
- massage rooms
- classic porn indian
- erotic lesbian
- redhead squirt
- homemade girlfriend
- stockings suspenders
- hard anal
- gigantic tits
- movie sex scene
- veronica avluv solo
- vintage milf
- big booty ebony anal
- oriental anal
- smoking bbw
- handjob table
- young busty
- 50 plus
- two mature
- bbc cum
- shaking orgasms
- tight creampie
- gianna michaels bbc
- britney amber blowjob
- screaming orgasm
- oiled tits
- oil handjob
- valentina nappi interracial
- hairy mature solo
- dirty
- mexican porn
- mom solo
- pov anal
- sixty nine
- skinny slave
- bbc deepthroat
- shalina devine anal
- lesbian step sister
- fuck for money
- kendra lust lesbian
- sister caught masturbating
- big tits deepthroat
- japanese face fuck
- old man cock
- vintage lesbian
- interracial creampie gangbang
- ebony milf big tits
- teen lesbian trib
- drunk woman
- blonde teen amateur
- wake up n fuck
- casting woodman
- christmas threesome
- fake agent casting
- bbc swallow
- three girls pov
- amateur drunk wife
- big booty white
- bareback
- lesbians caught
- black cougar
- sexy dress
- laundry room
- joslyn james anal
- dani daniels pov
- milf group
- tori black solo
- cherry torn anal
- 21 naturals
- russian milf
- nylon foot job
- french bbw anal
- monster dildo
- skinny dildo
- hairy girls
- teen bbc anal
- black daddy
- interracial shemale
- homemade facial
- cum sharing
- piss in pussy
- fakings spanish
- wife bbc
- lesbian games
- lesbian stepmom
- mia khalifa pov
- mature french anal
- dirty pussy
- objects insertion
- young russian couple
- mature doctor
- hairy french
- german secretary
- russian skinny milf
- best friends dad
- monique alexander anal
- lunch break
- perfect ass
- lesbian domination
- mature and boy
- blonde bukkake
- lesbians squirt
- shemale threesome
- valerie kay interracial
- german gangbang
- lesbian anal
- vanessa veracruz lesbian
- skinny ass
- big facial
- cum orgy
- big dick blowjob
- british amateur
- latina creampie
- big booty webcam
- big boobs shower
- euro orgy
- extreme facefuck
- anal massage
- secretary
- nuru massage lesbian
- japanese shaved pussy
- lesbian grannies
- cum compilation
- big gangbang
- private society
- hot mature
- girlfriend blowjob
- lesbian anal threesome
- amazing tits
- valentina nappi gangbang
- gloryhole compilation
- skinny teen
- teens threesome
- huge anal toy
- drunk fuck
- black mistress
- black cock handjob
- convulsing orgasm
- nose hook
- black teen amateur
- latina glasses
- krissy lynn anal
- busty russian teen
- hairy beauty
- redhead secretary
- asian pornstar
- debt interracial
- cute indian
- muscle mature
- hot threesome
- stockings masturbation
- big tit creampie
- latex masturbation
- riley reid anal
- black girl pov
- madison ivy threesome
- busty outdoor
- ftv girl
- euro teen anal
- clit licking
- lesbians strap on
- wifes sister
- black cocks gangbang
- april oneil lesbian
- schoolgirl solo
- asshole close up
- collar slave
- finger ass
- amy anderssen interracial
- white booty
- submissive interracial
- mommy anal
- asian model
- milf teen anal
- pregnant big tits
- teen deep throat
- lesbian machine
- young blowjob
- german milf and boy
- britney stevens anal
- bisexual amateur
- asian foot
- siri anal
- bride interracial
- lesbian gape
- big tit anal
- beautiful mature
- double ended dildo
- sexy mature
- amateur first anal
- bobbi starr bdsm
- vicki chase anal
- italian threesome
- french beauty
- pure 18
- beauty teen
- black girl solo
- mature anal dildo
- asian casting couch
- french ebony
- busty polish
- amateur granny anal
- mini dress
- ass licking lesbian
- beautiful boobs
- horse dildo
- triple anal
- big black cocks
- skinny gangbang
- stockings high heels
- bathroom strip
- ggg piss
- escort
- big black ass
- public lesbians
- hijab sex
- family gangbang
- huge gangbang
- outdoor orgy
- amateur interracial anal
- bbw bunny
- black monster
- sean michaels interracial
- piper perri lesbian
- sister anal
- hard nipples
- ass worship
- ftv dildo
- big dildo solo
- deepthroat cum
- british bdsm
- black pussy masturbation
- cute shemale
- doctor anal exam
- lesbian kissing
- teacher dp
- james deen rough
- german groupsex
- black bitch anal
- tight asian
- chubby gay
- school blowjob
- cute redhead
- 69 porn
- thick teen
- black schoolgirl
- hairy daughter
- sleeping fuck
- small tits lesbian
- petite lesbians
- tattooed bbw
- nasty lesbian
- dillion harper solo
- britney amber interracial
- taxi creampie
- petite teen anal
- office lesbians
- big booty bbw
- stepdad and daughter
- amateur wife anal
- hard dp
- tiny tits
- webcam fisting
- high heels footjob
- fat hairy
- asian anal creampie
- mature women
- piper perri threesome
- brother anal
- maid watches
- sex on the beach
- anissa kate dp
- dildo bike
- dress
- interracial sex
- enormous boobs
- pantyhose dildo
- prostitute anal
- extreme deepthroat
- jessica robbin anal
- south beach
- huge strapon
- thick ebony
- big tits bikini
- japan hairy
- japanese beauties
- squirt compilation
- tied gangbang
- short hair lesbians
- horny wife
- teen throat fuck
- tattoo teen
- library fuck
- friends mom
- lesbian tied
- gangbang party
- wow girls
- monster tits milf
- schoolgirl anal
- triple anal penetration
- mommys girl
- milf mia
- self piss
- katrina jade anal
- diamond foxxx threesome
- wet clothing
- ass fetish
- strapon femdom
- busty teens
- german brunette
- outdoor bdsm
- canadian milf
- shemale compilation
- nubiles films
- indian teen
- slave girl
- casting couch blonde
- pov pantyhose sex
- busty ebony teen
- sleeping girl
- big tits hentai
- asian cheerleader
- public pickup
- mature bbc anal
- sleep fuck
- first anal creampie
- asian idol
- bunny babe
- teen interracial dp
- dads fucking daughters
- slave training
- nikita bellucci anal
- amateur milf solo
- wife first time
- hard anal sex
- nina elle lesbian
- how to masturbate
- mike adriano anal
- naughty mom
- massage big tits
- vampire blowjob
- cheerleader pov
- anal creampie swallow
- thick white booty
- japanese stepmom
- park sex
- amateur deep throat
- fake taxi threesome
- wife swap
- fucking machine anal
- ava addams lesbian
- petite blonde
- ebony teen creampie
- feet domination
- pantyhose ass
- face down ass up
- gaping lesbians
- girls eating pussy
- missy martinez anal
- blonde bbc
- vintage mature
- nylon foot fetish
- fishnet lesbian
- aidra fox pov
- extreme gape
- live sex show
- sybian bondage
- amateur old young
- cum on ass
- fake taxi milf
- extreme puke
- first black
- sons friend
- rocco teens
- massage orgasm
- russian mature
- hairy chinese
- black tits
- ebony solo squirt
- deepthroat creampie
- classic anal
- naked on stage
- black cam
- big booty asian
- rachel roxxx pov
- small saggy tits
- mirror dildo
- cuckold husband
- black pussy spread
- mature pov
- self spanking
- best blowjob compilation
- pink pussy
- pantyhose mom
- amateur big tits
- black girl anal
- pillow humping
- rocco anal
- brazzers massage
- amateur massage
- underwater blowjob
- drunk asian
- girlfriend drunk
- dog slave
- sell your gf
- busty asian milf
- aletta ocean anal
- big orgy
- alena croft anal
- wife gangbanged
- wife swapping couples
- plump teen
- skinny indian
- latina black
- wetting her panties
- drunk college
- granny blonde
- aj applegate lesbian
- dildo machine
- redhead amateur
- german webcam girl
- vintage maid
- skinny lesbian girls
- russian teen outdoor
- lelu love creampie
- old and young gangbang
- feet cum
- vintage redhead
- steve holmes anal
- lesbian story
- solo piss
- skinny ebony teen
- gothic
- skinny boy
- lesbian agent
- blonde milf anal
- fake tits pov
- stepmom creampie
- first video
- dutch porn
- mature lingerie
- mom and boy
- crotchless panties
- brutal throat fuck
- asian dp
- young cock
- mom gangbang
- european porn
- deep fisting
- ebony machine
- petite teen solo
- fuck me
- big dick pov
- milf double penetration
- webcam masturbation
- drunk mom
- mom teaches
- ebony deep throat
- close up penetration
- lesbian vibrator
- hot sex
- perfect asian
- huge tits lesbian
- molly jane anal
- asian riding
- busty redhead milf
- lesbian milf strapon
- drunk girls
- reverse cuckold
- young girl anal
- london keyes lesbian
- sinn sage strapon
- big fake tits
- fat lesbians
- german lesbian
- perfect handjob
- great body
- vintage threesome
- fat latina
- anal dildo
- amwf creampie
- schoolgirl blowjob
- latex catsuit
- busty pregnant
- old and young massage
- black milf anal
- outdoor footjob
- chloe amour anal
- big clits
- milf cuckold
- face pissing
- first time audition
- two teens anal
- booty lesbian
- college slut
- marica hase interracial
- sexy granny
- doggy style creampie
- stepsister blowjob
- blowjob queen
- rimming threesome
- standing dp
- nipple piercing
- bizarre anal
- black lesbian mom
- strapon lesbians
- anal pounding
- dripping wet
- hairy pov
- katja kassin anal
- hairy indian
- amateur dogging
- japanese pussy
- blonde short hair
- huge ass
- dani daniels threesome
- bet wife
- sex slave
- while on phone
- asian creampie
- black dp
- russia teen
- teen black cock
- amateur bikini
- chloe amour lesbian
- big boobs lesbian
- hardcore deepthroat
- busty bikini
- hairy teen solo
- big black dick anal
- beautiful asian
- big tits joi
- latina bukkake
- yoga fuck
- mother teaches
- pov threesome
- clothed ladies
- white porn
- big ebony ass
- mom in kitchen
- porn star
- feet fetish
- mom caught son
- asian ass fuck
- lesbian nylon
- lesbian panties
- cheerleader porn
- swallowing sperm
- ebony pissing
- squirting orgy
- fishnet feet
- beach anal
- gay bears
- breasts
- reverse gangbang
- huge fat tits
- eva karera interracial
- glory hole big
- indian creampie
- sloppy blowjob pov
- julia ann anal
- young lesbian ass
- shemale anal
- young schoolgirl
- perfect natural tits
- porn shoot
- wrestling fuck
- kendra lust anal
- brazzers lesbian
- couple seduce teen
- pissing panties
- hairy solo
- pantyhose anal
- german mistress
- british piss
- suck and swallow
- creampie eating
- gangbang girl
- latina lesbians
- screaming amateur
- whipped ass
- tattooed pussy
- homemade anal threesome
- alien sex
- cuckold gangbang
- teen throat
- savannah fox anal
- japanese milf uncensored
- big wet tits
- bbc porn
- lesbian strap on anal
- nasty ffm
- busty curvy
- sleeping lesbian
- flexible fuck
- bondage slave
- lesbian doctor
- big boobs
- czech threesome
- milf seduces boy
- cathy heaven anal
- first time anal
- round and brown
- bubble ass
- orgasm fuck
- young teen solo
- teen masturbating
- nasty granny
- alexis texas solo
- enema teen
- mom dp
- casting compilation
- best cumshot compilation
- perfect anal
- nipples pull
- ebony babysitter
- ball crush
- extreme anal insertion
- masturbation orgasm
- nerdy anal
- amateur teen
- big tit wrestling
- slim brunette
- husbands boss
- riding creampie
- elegant mature
- giant tits
- tattoo lesbian
- joy bear
- model
- japanese pov blowjob
- lesbian group sex
- hentai compilation
- asian daughter
- big booty interracial
- big booty teen
- wrestling trib
- redhead public
- pussy compilation
- juicy pussy
- big tit threesome
- ebony pool
- nurse pov
- mind control
- stepmom teaches
- lesbian bondage
- milf slave
- tricked into fucking
- shemale domination
- face fucking
- outdoor fisting
- lesbian massage
- boots and stockings
- asian stepmom
- hubby watches wife
- big boobs massage
- old man young girl
- teen lesbians
- piss drinking
- teen interracial
- black teen
- desi wife
- money for sex
- cuckold feet
- big tits boss
- massage room
- german blonde anal
- lesbian hotel
- interracial office
- kinky mature
- latin ass
- huge tits strip
- flat chested teen
- white girl sucks black dick
- webcam girl
- sexy milf
- pov step
- anal toying
- cum dumpster
- pussy destroyed
- huge anal dildo
- nasty milf
- outdoor sex
- big tits
- big tits solo
- big boobs latina
- chubby amateur teen
- beurette anal
- kama sutra
- lucky nerd
- viv thomas
- asian cock
- blonde dp
- handjob cumshot compilation
- trina michaels interracial
- toilet fuck
- chubby fingering
- cross-dressing
- beach cum
- japanese nurses
- spread ass
- tan lines anal
- petite redhead
- gay amateur
- magic wand orgasm
- slave fuck
- boss secretary
- big cock compilation
- bbw lesbian
- lexi belle solo
- black monster cock
- ebony bbw dildo
- faketaxi anal
- bodybuilder lesbian
- kitchen threesome
- tight pussy
- porn debut
- lisa ann dp
- dirty wife
- busty creampie
- brunette milf anal
- asian pantyhose
- kayden kross anal
- bi threesome
- czech mature
- mistress t handjob
- tall milf
- surprise fuck
- czech bitch
- blackmailed into sex
- briana banks dp
- biggest cock
- asian anal teen
- redhead riding
- elexis lesbian
- mature spread
- bbw tits
- stepdaughter anal
- creampie orgasm
- mom and daughter blowjob
- the upper floor
- homemade cumshot compilation
- teen piss
- teen blonde anal
- pregnant dildo
- samantha saint threesome
- facesitting femdom
- passionate lesbian
- bbc anal
- facial cumshots
- celebrity sex tape
- big pussy lips
- japanese massage sex
- giant ass
- big tits latex
- big booty
- colombian ass
- daughter and dad
- public masterbation
- first sex
- belly down
- first creampie
- milf bbc
- naughty teacher
- daphne rosen lesbian
- bangbus anal
- redhead cougar
- old man creampie
- bottle in ass
- milf and young
- bff threesome
- public jerk off
- lela star interracial
- double anal creampie
- old man and teen
- lucky guy threesome
- public pick up
- twistys solo
- fisting fun
- casting creampie
- bondage porn
- digital playground
- big ass teen anal
- misty stone lesbian
- homosexual
- cam girls
- pretty pussy
- tight porn
- tricky old teacher
- busty asian
- hooker car
- curly ebony
- shemale cartoon
- naked news
- plump amateur
- spanish interracial
- daughter facial